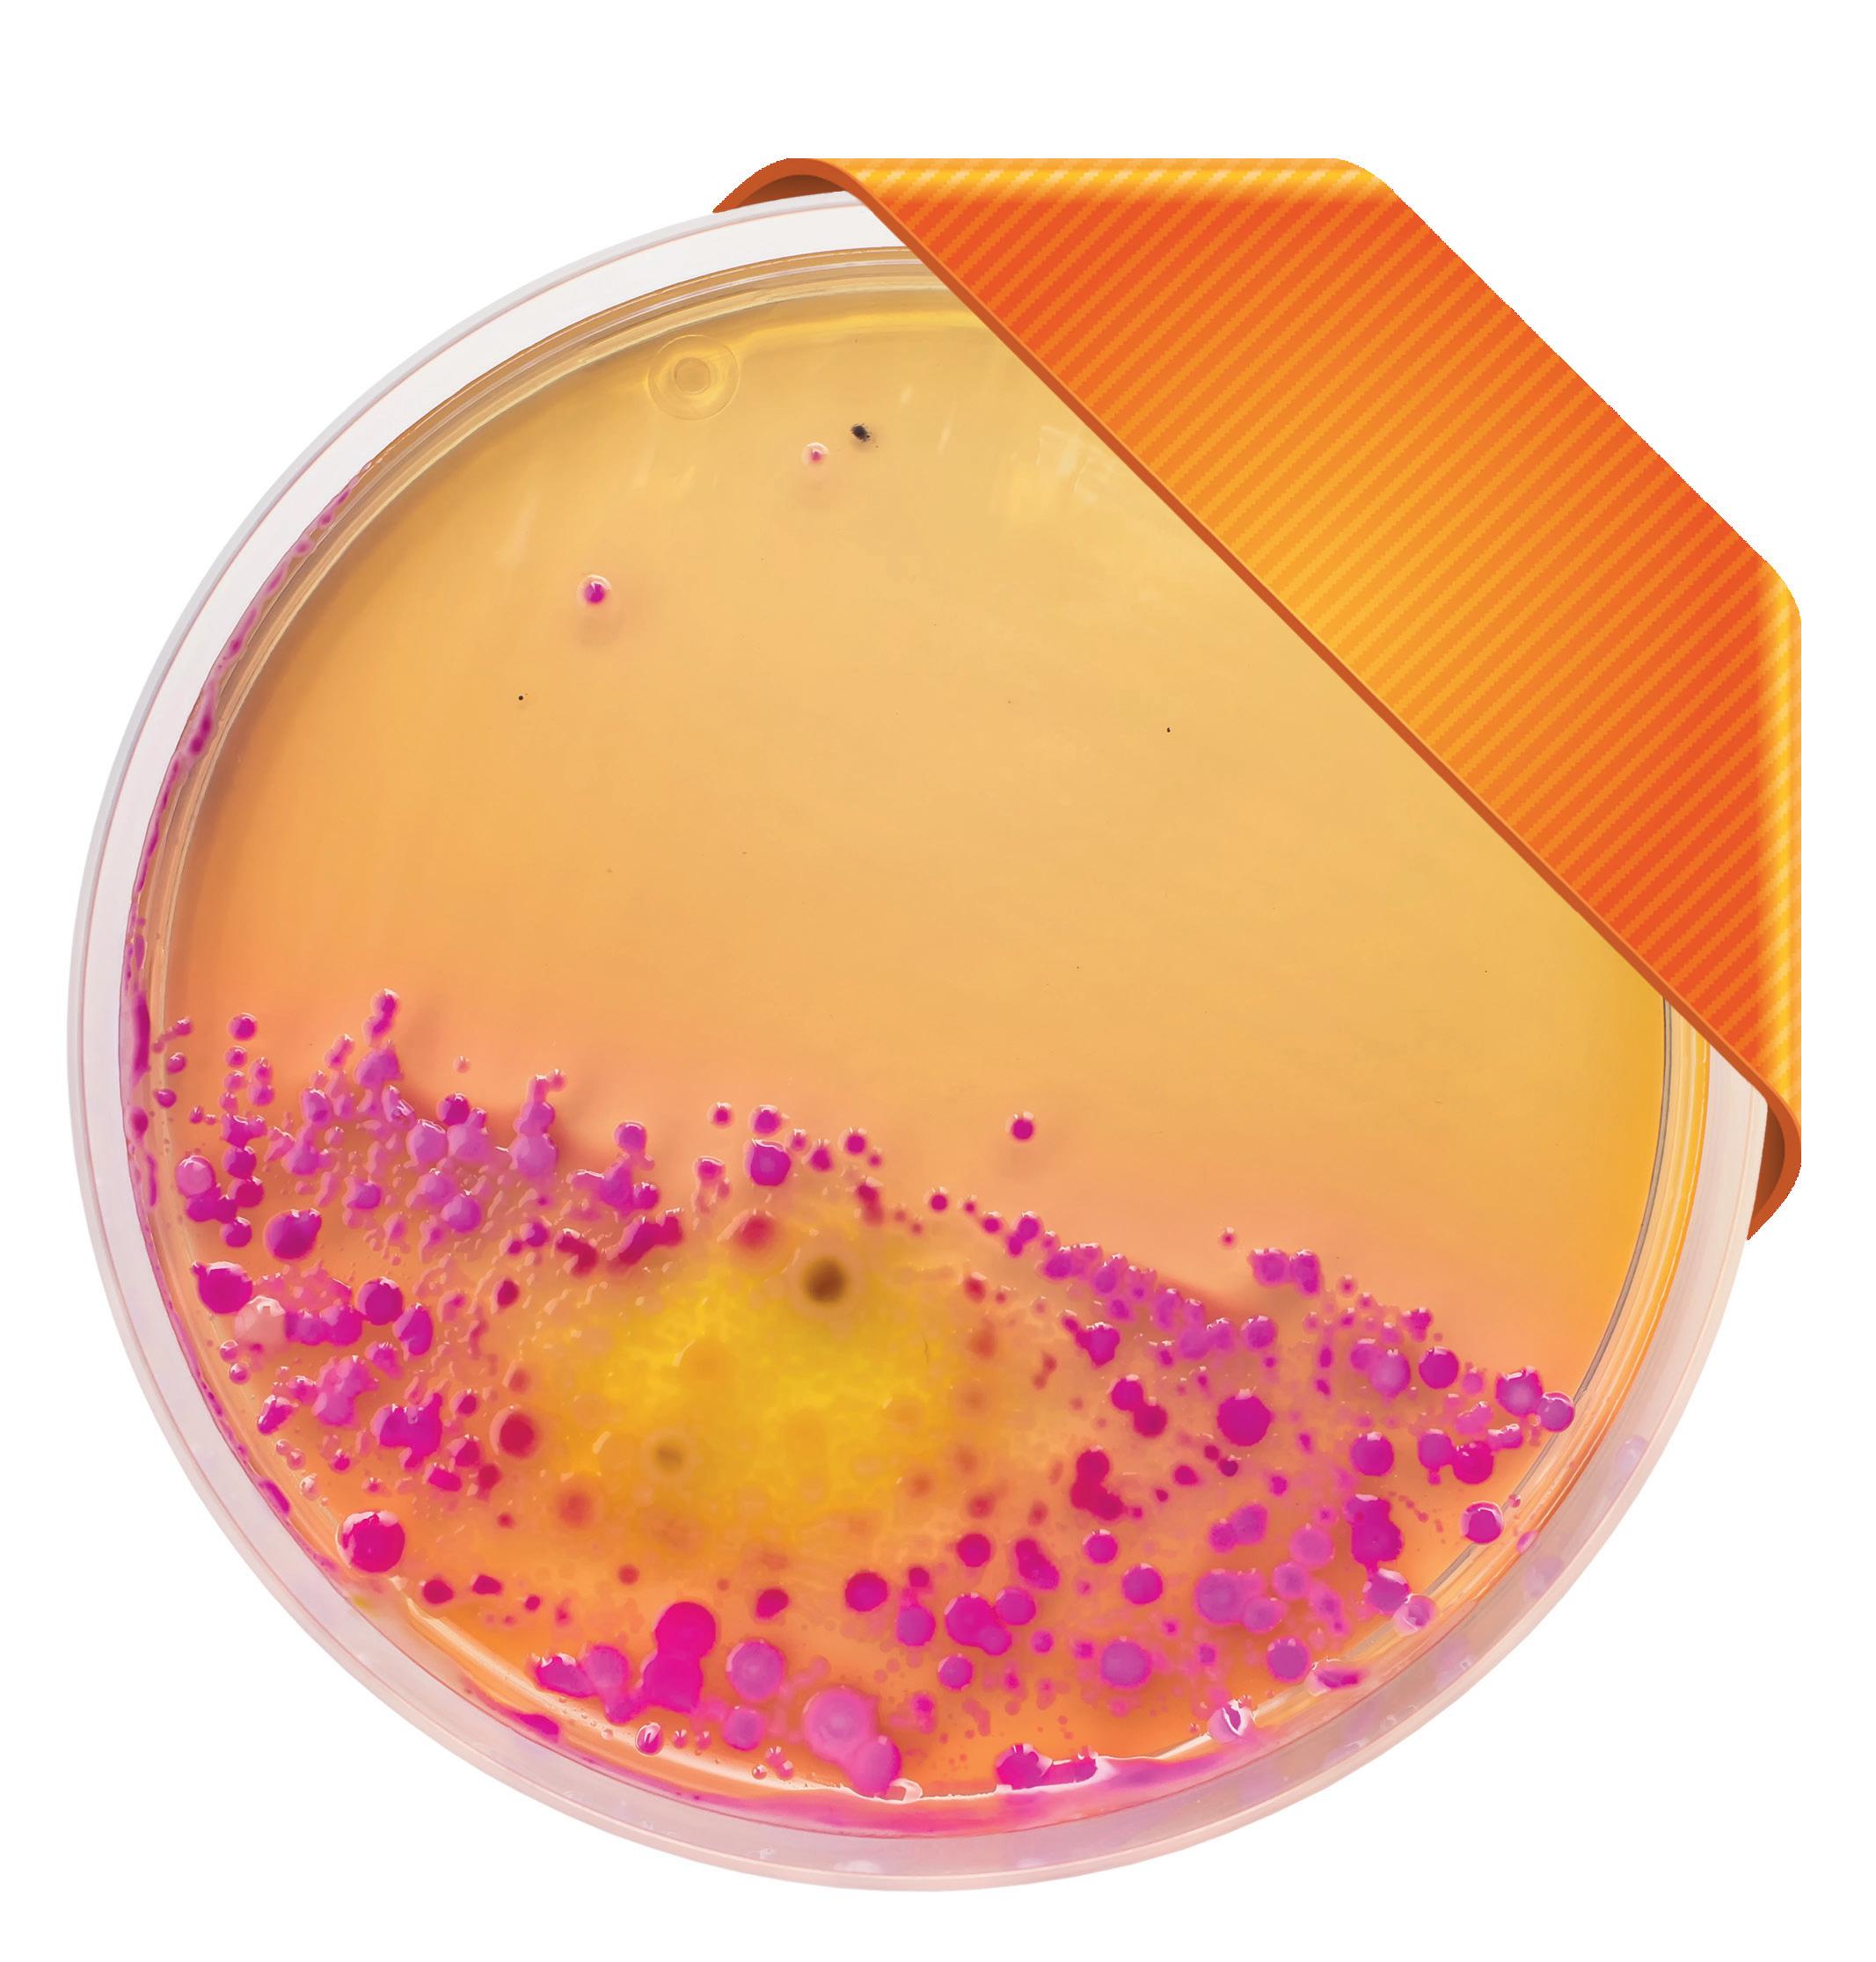

Moderne Schmerzmedizin: Möglichkeiten & Grenzen
„Weder sich noch
andere gefährden“
WORDRAP über otologische Probleme & Sport

Hausärzt:in DIALOG
Gynäkologie–Urologie
Von Brustkrebsfrüherkennung bis Zystitis
FachkurzinformationsieheSeite48

Gutes gehört auf die Titelseite
Erinnern Sie sich an Memantin Aristo®?


Österreichische Post AG, MZ16Z040661M, 32. Jahrgang, RegionalMedien Austria GesundheitRMA Gesundheit GmbH, Am Belvedere 10 / Top 5, 1100 Wien 06/2023 Praxis-Magazin für Primärversorgung mit Sonderteil Pharmazie
DASEIN
SCHLUSS MIT MAUERBLÜMCHEN -
EKO Kassenfrei! Gelbe RE2 Box www.aristo-pharma.at
TABLETTEN TEILBAR
Neuerungen beim e-Rezept
Suchtgift-Verschreibungen mit Ausnahme von Substitutionstherapie
Ab 1.7.2023 können Suchtgifte mit Ausnahme von Substitutionstherapie via e-Rezept vollständig elektronisch verschrieben werden. Ein elektronisches Suchtgift-Kennzeichen im hochsicheren e-card System ersetzt dabei die bisherige Suchtgift-Vignette. Das bedeutet für Sie:
Erstellen Sie das e-Rezept wie gewohnt. Enthält es ein Suchtgift, müssen Sie das Suchtgift-Kennzeichen verpflichtend markieren Ein Ausdruck erfolgt wie bei allen e-Rezepten nur auf ausdrücklichen Wunsch der Patientin bzw. des Patienten, wobei die Kennzeichnung als Suchtgift nicht am Ausdruck ersichtlich ist. Kleben Sie in diesem Fall keine Vignette!
In der Apotheke kann die Suchtgift-Verschreibung mit der e-card eingelöst werden, alternativ auch mit dem e-Rezept Code bzw. der Rezept ID (REZ-ID) vom Smartphone oder e-Rezept Ausdruck. Die Eingabe der Sozialversicherungsnummer ist –wie bei allen e-Rezepten – nicht ausreichend!
Suchtgifte mit Ausnahme von Substitutions-Dauertherapie können auch auf Blankoformularen verschrieben werden (z.B. bei einem Hausbesuch oder Stromausfall). In diesem Fall muss eine Vignette geklebt werden!
Ausgenommen von der Umstellung bleiben Substitutionsmittel:
Substitutions-Dauertherapien sind weiterhin ausnahmslos auf den bekannten Formularvordrucken „Substitutionsverschreibung“ und mit Vignette zu verordnen.
Substitutions-Einzelverschreibungen können, jedenfalls mit Vignette, auf dem Formularvordruck „Substitutionsverschreibung“ oder auch auf Blankoformularen erfolgen.
e-card Stecken: Verpflichtend bei Anwesenheit der Patientin bzw. des Patienten
Ist die Patientin bzw. der Patient in der Ordination anwesend, muss die e-card verpflichtend gesteckt bzw. kontaktlos via NFC ausgelesen werden (§ 4 e-card Gesamtvertrag). Eine Admin-Karten Konsultation ist nur dann zulässig, wenn die e-card nicht gesteckt werden kann (defekt, gesperrt, gestohlen, verloren). Die Patientin bzw. der Patient muss die e-card beim nächsten Besuch in der Ordination auf jeden Fall nachbringen, und die Admin-Karten Konsultation muss durch Stecken bzw. Nutzung der kontaktlosen NFC-Funktion der e-card nachsigniert werden.
e-Rezepte bei defekter, gesperrter, gestohlener oder verlorener e-card
Für Patientinnen und Patienten, deren e-card defekt, gesperrt, gestohlen oder verloren wurde, oder zu deren gesperrter e-card ein elektronischer e-card Ersatzbeleg (ECEB) vom zuständigen Krankenversicherungsträger eingetragen ist, können Sie e-Rezepte mit Admin-Karte und Sozialversicherungsnummer ausstellen.
Bis sie eine neue e-card besitzen, benötigen betroffene Patientinnen bzw. Patienten für die Einlösung den e-Rezept Code oder die Rezept ID (REZ-ID)! Der elektronische e-card Ersatzbeleg gilt nicht in der Apotheke, sondern nur in Ordinationen! Mit einer gesperrten oder defekten e-card ist in der Apotheke kein Zugriff auf e-Rezepte möglich!
Die Eingabe der Sozialversicherungsnummer ist nicht ausreichend!
Bei Anwesenheit der Patientin bzw. des Patienten in der Ordination übergeben Sie einen e-Rezept Ausdruck.
Bei Abwesenheit der Patientin bzw. des Patienten geben Sie die 12-stellige Rezept ID telefonisch durch.
Alternativ können Versicherte den e-Rezept Code oder die Rezept ID (REZ-ID) auch aus den kostenlosen Apps der Sozialversicherung abrufen und in der Apotheke direkt auf dem Smartphone vorweisen.
Mehr auf www.chipkarte.at/e-rezept
BEZAHLTE ANZEIGE
Ethik – eine mögliche Therapie fürs Gesundheitswesen?
Ja, das gibt es wirklich und es ist gut so: ein Wiener Denklabor für Medizinethik. Dieses soll als Diskussionsplattform für Medizin, Gesundheitswesen und Gesundheitswirtschaft dienen. Und es bietet ab sofort maßgeschneiderte Fortbildungen für Organisationen und Personen im Gesundheitswesen an.
Das neue Denklabor ist ein zentrales Gremium des 2021 gegründeten gemeinnützigen Vereins AescuLAB e. V. Führende Fachpersonen aus Medizin, Ethik, Gesundheitsberufen, Rechts-, Geschichts- und Sozialwissenschaften, Psychologie, Philosophie, Kultur, Wirtschaft und Recht tauschen sich darin regelmäßig aus und erarbeiten die fachliche Basis für Projekte des Vereins. Darüber hinaus gibt es Veranstaltungen wie die Ethik Biennale in Venedig und einen Podcast.
Ein Fokus des Denklabors liegt auf der Organisationsethik. Vereinsobmann Prof. DDr. Karl-Heinz Wehkamp ist überzeugt: „ Der langfristige Erfolg einer medizinischen Organisation wird künftig davon abhängen, ob Ärzteschaft, Therapeut:innen, Pflege, Management und Verwaltung eine gemeinsame Wertebasis haben und diese täglich authentisch leben. Wir verstehen Ethik als lebendigen Ordnungsrahmen, der allen medizinischen, therapeutischen und wirtschaftlichen Entscheidungen, der Patient:innenkommunikation und der Zusammenarbeit des Personals Orientierung gibt.“
Großer Aufklärungs- und Lernbedarf
Für das erste Curriculum des Bildungsforums zeichnet Prof.in DDr.in Barbara Maier, Vorständin der Abteilung für Gynäkologie und Geburtshilfe der Klinik Ottakring, Philosophin und Ethikerin, verantwortlich: „ Es gibt großen Aufklärungsbedarf in Bezug auf die Möglichkeiten und Vorteile einer angewandten Ethik in Gesundheitsorganisationen“, hält
TERMIN

Das Curriculum Ethik in Kliniken findet an folgenden Terminen statt: 23. & 24. Juni, 28. & 29. Juli, 1. & 2. September, 6. & 7. Oktober, 3. & 4. November, 15. & 16. Dezember 2023, jeweils freitags von 17 bis 19 Uhr und samstags von 9 bis 18 Uhr. Info & Anmeldung: aesculab.eu/denklabor/#aesculab-bildungsforum
sie fest. „Um der Krise des Gesundheitswesens zu begegnen, wird meist an funktionalen Stellschrauben gedreht. Budgets und Ressourcen werden umverteilt, Managementstrukturen neu aufgestellt. Das alles kann sinnvoll sein. Langfristiges Gelingen ist aber nur dort möglich, wo eine Wertehierarchie das Wohl von Patient:innen in den Mittelpunkt stellt und sich daraus medizinische Entscheidungen, Kommunikationsmöglichkeiten, Ökonomie und Management ableiten “
Eine gemeinsam getragene Ethik schaffe und sichere in diesem Sinne das Wohl von Patient:innen und von allen, die im Gesundheitswesen tätig sind, und ermögliche ein gesundes und ressourcenschonendes Wirtschaften. Die ethische Fortbildung will den Teilnehmenden darüber hinaus konkrete Entscheidungshilfen für „ Dilemmasituationen“ im Berufsalltag bieten.

Ethische Aspekte der Schmerztherapie
Auch unser diesjähriger Hausärzt:in
Dialogtag Anfang Juni in Linz behandelte ein Thema, das mit vielen ethischen Fragestellungen Hand in Hand geht: „Moderne Schmerzmedizin: Möglichkeiten und Grenzen. Von der Pädiatrie bis zur Palliativmedizin“. Im Rahmen einer Podiumsdiskussion sprachen namhafte Vertreter:innen von Ärzteschaft, Selbsthilfe, Politik und ÖGK darüber, was gegen Lücken in der Versorgung von Schmerz- und Palliativpatient:innen getan werden kann. Spannende Statements und nette Fotos finden Sie dazu in unserer aktuellen Titelgeschichte ab Seite 14!
Eine interessante Lektüre und einen schönen Sommer wünscht Ihnen
Ihre Mag.a Karin Martin Redaktionsleiterin RegionalMedien Gesundheit, karin.martin@regionalmedien.at
Hausärzt:in
© RegionalMedien Gesundheit
Editorial
3 Juni 2023
medizinisch
06 Eine enge Beziehung Wie Mikrobiom, Biodiversität, Umwelt und Ernährung die Gesundheit bestimmen
10 Einsatz unter Palmen Wie vorgehen bei Unfällen und medizinischen Notfällen in fernen Gefilden?
20 „Sportverletzungen sind im Sommer häufig“ Patient:innen mit Distorsion oder Kontusionen in der hausärztlichen Praxis
22 „Weder sich selbst noch andere gefährden“


WORDRAP über otologische Probleme im Zusammenhang mit Sport
25 Laufende Nase ... Eine Rhinorrhoe kann unterschiedliche Ursachen haben
34 Postvirale Zustände Welche Patient:innen brauchen Rehabilitation nach COVID-19?
politisch
THEMA DES MONATS
14 Schluss mit dem MauerblümchenDasein
Moderne Schmerzmedizin: Möglichkeiten & Grenzen
19 Prävention im Mittelpunkt
Das war der 29. ÖSGKongress 2023
pharmazeutisch
37 Erfreuliche Ergebnisse
Fast ein Drittel mehr innovative Arzneimittel im Jahr 2022
38 Wirkmechanismen, Wirtsbäume und Selbstregulation
Die Mistel gilt als eine der ältesten Heilpflanzen – mit großem Erfolg wird sie heute in der Onkologie angewendet
45 Zukunftsfittes Gesundheitssystem Klimakompetenz soll in der Berufsausbildung stärker verankert werden
46 Arzt Sicht Sache „GPT: Software zur Schwarmverblödung?“
47 Impressum
28 Im Urlaub brennt‘s Auch bei erhöhtem Risiko Harnwegsinfekte in den Griff bekommen
30 „Nicht immer sind Keime im Spiel”
Univ.-Prof.in Dr.in Doris Maria Gruber über das Krankheitsbild der Zystitis in unterschiedlichen Lebensphasen
32 Brustkrebserkennung –neue Technologien in der Diagnose
Die Mammografie liefert nicht bei allen Frauen gleich gute Ergebnisse
Ohrenprobleme können sich nicht nur unter Wasser ergeben.

Hausärzt:in Inhaltsverzeichnis
© shutterstock.com/Ja Crispy
extra © shutterstock.com/Rich Carey 22 © shutterstock.com/slonme 10 38
Die Mistel gedeiht auf unterschiedlichen Wirtsbäumen.
4 Juni 2023
Der NEUE NASENSPRAY mit 2-FACH-POWER bei ALLERGISCHER RHINITIS





Zwei Sprühstöße pro Nasenloch zweimal täglich1
* Indikationstext/ Regeltext lt. EKO: Zur Behandlung mäßig bis stark ausgeprägter Nasensymptome der mittelschweren bis schweren allergischen Rhinitis bei PatientInnen ab 12 Jahren, wenn eine Monotherapie entweder mit einem Antihistaminikum oder intranasalen Corticosteroid nicht ausreichend ist.

Mometasonfuroat/Olopatadin
1 , * AT-RYA-10-02-2023
Fachinformation Fachkurzinformation siehe Seite 48
1. Ryaltris™
Eine enge Beziehung

Wie Mikrobiom, Biodiversität, Umwelt und Ernährung die Gesundheit bestimmen



Hausärzt:in medizinisch 6 Juni 2023
©
SerieGASTRO
shutterstock.com/grebcha, sarayut_sy, kamilpetran, Elena Eryomenko, Maryna Marchenko, phive
Ihr [ lokales ]
Darm-Antibiotikum
Colidimin® bei



• unkomplizierten Divertikelerkrankungen

• hepatischer Enzephalopathie
• Reisediarrhoe
• bakteriellem Überwucherungs-Syndrom (SIBO)
7 Juni 2023
GPB.COL 221101
© privat > Fachkurzinformation siehe Seite 48
GASTAUTOR: Prof. Mag. DDr. Martin Grassberger Biologe an der Universität Wien, Inhaber des Lehrstuhls für Gerichtsmedizin an der SFU Wien, Umwelt- und Ernährungsmediziner
Abbildung: Überblick über die wichtigsten relevanten Wechselwirkungen zwischen Umwelt, Mikrobiota und menschlichem Holobionten.
Quelle: modifiziert und ergänzt nach Flandroy L et al., Sci Total Environ. 2018 Jun 15;627:1018-1038.
X HAUSÄRZT:IN-Buchtipp
Das unsichtbare Netz des Lebens Von Martin Grassberger Residenz Verlag 2021


Hausärzt:in medizinisch 8 Juni 2023
< © zVg
LEITLINIENGERECHTE THERAPIE BEI REFLUX
Neue S2k-Leitlinie empfiehlt Alginate
ALGINATSCHUTZBARRIERE
Alginate gewinnen stetig an Bedeutung bei der Behandlung von Refluxsymptomen. In Deutschland hat nun die DGVS (Deutsche Gesellschaft für Gastroenterologie, Verdauungs und Stoffwechselkrankheiten) Alginate in ihrer jüngst veröffentlichten aktualisierten „S2kLeitlinie Gastroösophageale Refluxkrankheit (GERD) und eosinophile Ösophagitis“ mit aufgenommen.*,1 Alginate spielen demnach künftig eine wichtige Rolle bei der leitliniengerechten Behandlung von Reflux.
Alginate für NERD Therapie empfohlen
Die neue Leitlinie empfiehlt Alginate für die Behandlung von Patienten mit nichterosiver Refluxkrankheit (NERD).1 Zuvor wurden für die Therapie mit niederpotenten Medikamenten lediglich Antazida und H2-Rezeptorantagonisten empfohlen.2 Gleiches gilt für das Behandeln typischer Refluxbeschwerden „ohne Alarmsymptome“: Hier sind laut Leitlinie Alginate für die probatorische Symptomkontrolle geeignet.1
Alginate können Acid Pocket eliminieren
Erstmalig wird in der der aktualisierten Leitlinie die sogenannte Acid Pocket beschrieben und erklärt. Die Acid Pocket ist ein Reservoir für Säurereflux, das sich im Magen unterhalb des Übergangs zum Ösophagus bildet. Mittels Alginat könne man diese Acid Pocket eliminieren – mit Antazida gelinge dies jedoch nicht, heißt es weiter in der neuen Leitlinie.1
Alternative Empfehlungen für GERD Therapie
Ebenso neuert sich die Empfehlung für PPI-Patienten mit persistierenden Refluxbeschwerden. Alternativ zum Wechsel auf einen anderen PPI oder zur Dosisverdoppelung rät das Leitlinien-Update zur Kombination des PPI mit Alginat – entweder kontinuierlich 4x am Tag oder als Add-on bei Bedarf. Und insbesondere wenn der Reflux im Rahmen einer GERD nachts auftritt, sind Alginate laut der aktualisierten Leitlinie ein probates Mittel – sie können alternativ zu einem PPI unmittelbar vor dem Schlafengehen eingenommen werden.1
Auch während der Schwangerschaft verträglich
Bei der Behandlung von Refluxbeschwerden bei Schwangeren haben sich Alginate als sichere Option bewährt: Im empfohlenen Step-up Management zählt die neue Leitlinie diese erneut an vorderster Stelle neben Antazida auf 1
Vielfältige Einsatzmöglichkeiten von Alginaten mit GAVISCON
Erhältlich sind Alginate im Produkt Portfolio von GAVISCON: Mit GAVISCON Liquid Sachets bietet Reckitt Benckiser das passende Format bei säurebedingten und gastroösophagealen Reflux-Symptomen sowie in der Schwangerschaft und Stillzeit.

1. Deutsche Gesellschaft für Gastroenterologie, Verdauungs- und Stoffwechselkrankheiten e.V. (DGVS; Hrsg.). S2k-Leitlinie: Gastroösophageale Refluxkrankheit, AWMF Register Nr. 021-013, März 2023, https://www.dgvs.de/wp-content/uploads/2023/03/LL-Reflux_Leitlinie_final_13.03.23.pdf (zuletzt aufgerufen 15.03.2023).
2. Deutsche Gesellschaft für Gastroenterologie, Verdauungs- und Stoffwechselkrankheiten e.V. (DGVS; Hrsg.). S2k-Leitlinie: Gastroösophageale Refluxkrankheit, AWMF Register Nr. 021-013, Stand 2014.
Gaviscon Liquid Sachets Mint Suspension zum Einnehmen.
Qualitative und quantitative Zusammensetzung: 10 ml Suspension enthalten: 500 mg Natriumalginat, 267 mg Natriumhydrogencarbonat und 160 mg Calciumcarbonat. Sonstige Bestandteile: Methyl (4-hydroxybenzoat) (E218) 40 mg/10 ml, Propyl (4-hydroxybenzoat) (E216) 6 mg/10 ml, Carbomer, Saccharin-Natrium, natürliches Minz-Aroma, Natriumhydroxid, gereinigtes Wasser. Anwendungsgebiete: Behandlung der Symptome des gastro-ösophagealen Reflux wie saures Aufstoßen, Sodbrennen und Verdauungsstörungen (infolge von Reflux), z.B. nach Mahlzeiten oder während der Schwangerschaft oder bei Patienten mit Beschwerden infolge von Refluxösophagitis. Gegenanzeigen: Überempfindlichkeit gegen die Wirkstoffe Natriumalginat, Natriumhydrogencarbonat und Calciumcarbonat oder einen der sonstigen Bestandteile, einschließlich Methyl-4-hydroxybenzoat (E 218) und Propyl-4-hydroxybenzoat (E 216). Pharmakotherapeutische Gruppe: Andere Mittel bei peptischem Ulkus und gastroösophagealer Refluxkrankheit. ATCCode: A02BX13. Pharmazeutischer Unternehmer: Reckitt Benckiser Deutschland GmbH, Darwinstrasse 2-4, 69115 Heidelberg, Deutschland. Verschreibungspflicht/Apothekenpflicht: Rezeptfrei, apothekenpflichtig. Die Informationen zu den Abschnitten Dosierung, Warnhinweise und Vorsichtsmaßnahmen für die Anwendung, Wechselwirkungen, Fertilität, Schwangerschaft und Stillzeit sowie Nebenwirkungen und Gewöhnungseffekte sind der veröffentlichten Fachinformation zu entnehmen. Stand der Information: 10/2020. GAV013

Anzeige
RKT-M-15906
ACID POCKET
Einsatz unter Palmen
Serie Tropenmedizin, Teil 1: Wie vorgehen bei Unfällen und medizinischen Notfällen in fernen Gefilden?
Wir sehen eine stetige Zunahme von Reisenden mit besonderen gesundheitlichen Risiken/Vorerkrankungen, die oft sehr ausgefallene Aktivitäten planen. Bei der Einschätzung der Reisefähigkeit ist es essenziell, die Anpassungsfähigkeit in Bezug auf die jeweilige fremde Kultur mitzuberücksichtigen. Das gilt insbesondere bei Langzeitreisenden und sozialen bzw. anderen Hilfseinsätzen.

Die meisten Reisenden nehmen eine viel zu umfassende Reiseapotheke mit. Medikamente werden dann oft in sehr entlegenen Regionen zum ersten Mal verwendet, was zu großen „Ü berraschungen“ führen kann. Sinnvoll ist es daher, in einer Reisemedizinischen Sprechstunde die Reiseapotheke mit dem Patienten in Hinblick auf „Was ist wirklich notwendig? “ durchzugehen
und Ballast abzuwerfen. Medikamente sollten auf Hand- und Großgepäck aufgeteilt transportiert werden, Befunde eingescannt, evtl. ein internationales Attest (v. a. bei Mitnahme von Opiaten oder Injektionsmaterialien) ausgestellt werden. Vorsicht: Medikamentenfälschungen sind in exotischen Ländern häufig und täuschend echt gemacht. Die Folgen der Einnahme können fatal sein.
Oft überschätzt: medizinische Versorgung im Reiseland

Was tun, wenn sich die Krankheit während der Reise verschlechtert? Notfallstrategien (Adressen) und die Abklärung der medizinischen Versorgung im Reiseland (die meist massiv überschätzt wird) sowie eine ausreichende
Reiserücktrittsversicherung sind das Um und Auf. In diesem Kontext – und nicht erst bei medizinischer Notwendigkeit – ist die Formulierung „ medizinisch sinnvoll und vertretbar “ angebracht.
Es kann wichtig sein, vor Reiseantritt die Fluggesellschaft/Reederei über besondere Bedürfnisse in Zusammenhang mit der Erkrankung zu informieren, Stichworte: Transport, spezielle Sitzplätze für Behinderte, Sondermenüs für Diabetiker, Allergiker … Nicht unwesentlich ist zudem: Sind die Mitreisenden informiert? Beispiel Höhenbergsteigen: Können die Bergkameraden eine Hypoglykämie erkennen?
Diese ist z. B. leicht mit einem Höhenhirnödem zu verwechseln – bei Frühsymptomen eignet sich zur Diagnose einer Ataxie der „ Strichgang “



Hausärzt:in medizinisch 10 Juni 2023
©
shutterstock.com/slonme
©
privat
Als Ersthelfer bei Unfällen
Die meisten Reisenden fürchten sich vor Erkrankungen wie Malaria, Dengue, Chikungunya, Zika etc. oder vor sehr ausgefallenen, aber spektakulären Risiken wie Haiattacken. Natürlich ist eine adäquate Vorbereitung des Reisenden auf infektiologische Gefahren (mit Überprüfung des Impfstatus auch auf Kinderkrankheiten!) der zentrale Punkt jeder Reisemedizinischen Beratung. Diese ist sehr zeitintensiv: Ich selbst benötige dafür ca. 45 Minuten, oft mehrere Sitzungen. Dabei sollte aber nicht vergessen werden, auch auf die Prävention von Unfällen einzugehen. Alle 30 bis 90 Sekunden stirbt weltweit ein Mensch bei einem Verkehrsunfall. 90 % sind Kinder. Für den Ersthelfer am Unfallort steht immer die Eigensicherheit im Vordergrund. Banale, aber in der stressigen Situation häufig vernachlässigte Vorsichtsmaßnahmen sind etwa der Blick in den Rückspiegel vor dem Aussteigen aus dem Fahrzeug, das Absichern des Unfallplatzes u. Ä. m. Oft ist es hilfreich, sich an Flussdiagramme zu halten (ABCDE-Schema) und die Anwesenden vor Ort sinnvoll einzubinden, Stichwort „Rollenverteilung“: Einer regelt beispielsweise den Verkehr, ein anderer hilft bei der Lagerung.
GASTAUTOR: Dr. Bernhard Haberfellner Facharzt für Spezifische Prophylaxe und Tropenmedizin und Arzt für Allgemeinmedizin in Linz, tropenarzt.at

Ist der Notfallpatient selbst noch dazu fähig, kann man ihn ebenso einbinden, ihm z. B. seine eigene Uhr zum Halten geben und ihn damit ohne Hilfsmittel monitorisieren. Sobald er sie fallen lässt, weiß man, dass er sein Bewusstsein verloren hat.

Beim Notfallteam ist ein ständiger, zeitlich genau kontrollierter Wechsel unerlässlich, um Erschöpfung und damit eine ungenügende Versorgung des Patienten zu vermeiden. Das gilt umso mehr bei Hitze oder in beengten Situationen, etwa im Flugzeug. Ist die medizinische Situation unklar, lohnt es sich, sich kurz zurückzunehmen und zu überlegen, wie man die Arbeitsbedingungen optimieren könnte –z. B., indem man bei einer schwierigen Intubation eine Jacke unter dem Patientenkopf zusammenrollt. Besonders in den Tropen sollte man für ausreichende Wärme bei Notfallpatienten sorgen: Den Helfern ist in der Hitze des Gefechtes das rasche Auskühlen – mit den damit verbundenen Komplikationen, beispielsweise einer verschlechterten Blutgerinnung – oft überhaupt nicht bewusst. In der Folge gilt es, den Notfallpatienten rasch aus der Gefahrenzone zu bringen, an eine Kontrolle des Blutzuckers zu denken und am besten sofort einen Venflon zu legen. Merke: Die Hypoglykämie zählt zu den reversiblen Ursachen neurologischer Erkrankungen.
Gerade in entlegenen Regionen ist eine gute Vorausplanung essenziell. Eine Intubation sollte auf keinen Fall vorschnell erfolgen. Denn selten kann eine weitere adäquate Versorgung eines intubierten, analgosedierten Patienten gewährleistet werden.

> Fachkurzinformation siehe Seite 48
© privat
3 mg Tabletten Ivermectin
Therapeutischer Meilenstein2: Orales Ivermectin bei Scabies
• Hochwirksam
• Einfache und schnelle Anwendung

• Für gute Compliance der Patienten
Scabioral 3 mg Tabletten Qualitative und quantitative Zusammensetzung: 1 Tablette enthält 3 mg Ivermectin. Sonstige Bestandteile: Mikrokristalline Cellulose, vorverkleisterte Stärke (Mais), Butylhydroxyanisol, Magnesiumstearat. Anwendungsgebiete: Behandlung der gastrointestinalen
Strongyloidiasis (Anguillulosis); Behandlung einer vermuteten oder diagnostizierten Mikrofilarämie bei Patienten mit durch Wuchereria bancrofti verursachten lymphatischen Filariose; Behandlung der Skabies (verursacht durch Sarcoptes scabiei) bei Menschen. Die Behandlung ist gerechtfertigt, wenn die Diagnose der Skabies klinisch und/oder durch parasitologische Untersuchungen gesichert ist. Ohne eine gesicherte Diagnose stellt ein Pruritus allein keine Indikation dar. Gegenanzeigen: Überempfindlichkeit gegen den Wirkstoff oder einen der sonstigen Bestandteile. Pharmakotherapeutische Gruppe: Anthelmintika. ATC-Code: P02CF01. Packungsgrößen: 4 Stück. Inhaber der Zulassung: INFECTOPHARM Arzneimittel und Consilium GmbH, Von-Humboldt-Str. 1, D-64646 Heppenheim. Rezept- und apothekenpflichtig. Stand 02/2019. Weitere Angaben zu Warnhinweisen und Vorsichtsmaßnahmen für die Anwendung, Wechselwirkungen, Schwangerschaft und Stillzeit, Nebenwirkungen entnehmen Sie bitte der veröffentlichten Fachinformation.
Vertrieb: INFECTOPHARM · Arzneimittel und Consilium GmbH · Von-Humboldt-Straße 1 D-64646 Heppenheim. Kontakt: InfectoPharm Arzneimittel und Consilium GmbH · LeopoldUngar-Platz 2 /1. Stock / Stiege 2 · 1190 Wien · Tel.: 01/227 60 65-6060 · Fax: 01/227 60 65-6061 www.infectopharm.at · austria.kontakt@infectopharm.com
Vorgehen bei Anaphylaxie
Ein häufiger Notfall in den Tropen sind allergische Reaktionen, z. B. auf Insektenstiche, in der schwersten Ausprägung der anaphylaktische Schock: Zuerst sollte die Allergenzufuhr gestoppt werden (z. B. Insektenstachel entfernen), auf eine korrekte Lagerung geachtet und der Patient vor Wärmeverlust geschützt werden. Beachte: Eine schwere Anaphylaxie kann auch ohne jede kutane Symptomatik auftreten. Möglichst rasch sollten zwei großlumige Zugänge gelegt und 500-1.000 ml Kristalloid verabreicht werden; zusätzlich Sauerstoff (mind. 6-8 l) und, falls vorhanden, Notfallmedikamente:
• Adrenalin: 0,5 mg i. m./ EpiPen (WH alle 5-10 Min.): M. vastus lat.
• H1-Antagonist: Dibondrin 30 mg i. v.
• Solu-Dacortin: 250-500 mg i. v.
Stethoskop, Pulsoximeter (> 92 %) und RR-Manschette sind absolut ausreichend. Als Faustregel bei Anaphylaxie gilt: Je rascher der Beginn, desto schwerer der Verlauf. Wichtig ist, sich nach einer erfolgreichen Therapie nicht zufrieden „zurückzulehnen“, sondern daran zu denken, dass bei ca. 5-20 % nach zunächst wirksamer Therapie ein biphasischer oder protrahierter Verlauf innerhalb von sechs bis 24 Stunden auftreten kann, insbesondere bei Asthmatikern.
Intoxikationen und Verbrennungen

Aufgrund der oft unzureichenden oder komplett fehlenden Schutzvorkehrungen kommen Intoxikationen in tropischen Ländern sehr häufig vor. Auch hier sollte man wieder zuerst an den Eigenschutz denken (Handschuhe, Mundschutz, Schutzkleidung, Behandlung evtl. im Freien), die Giftzufuhr stoppen, wenn möglich ein Antidot verabreichen, das Gift asservieren und die Vitalparameter stabilisieren. Ebenso häufig sind Verbrennungen. Es gilt: Je schmerzhafter, desto oberflächlicher (die Gefäße sind ausdrückbar). Wichtig: Womit hat sich der Patient verbrannt? Öl und Strom etwa führen zu tiefen Verbrennungen, die Haut ist straff, die Nägel sind abziehbar.
REISEIMPFUNGEN IM ÜBERBLICK
(siehe auch Hausärzt:in 05/23, Coverstory „Reisen trotz Risiko“, ab S. 14)
Impfempfehlungen:

Gelbfieber, Japan B, Tollwut, Typhus, Meningokokken, Cholera, Influenza, FSME, …
Mögliche Impfvorschriften (Ein-/Ausreise):
Gelbfieber (für alle Reisenden ausgenommen Kinder unter 9 Monaten), Poliomyelitis (für alle Reisenden, die sich länger als 4 Wochen im Land aufhalten), Meningokokken (je nach Anlass, z. B. Hadsch- oder Umrah-Pilger).
Reiseimpfungen nach Regionen: gesundheit.gv.at/leben/gesundheitsvorsorge/reisemedizin/ reiseimpfungen.html, crm.de
O O O O O HO O O O O O OH O OH A8001344-03-0323
Nobelpreis-Wirkstoff Ivermectin1
1 Ōmura S, Campbell WC. Nobelpreis für Physiologie oder Medizin 2015 für die Entdeckung von Ivermectin. 2 Kirchner M. Skabies (Krätze). RKI-Ratgeber für Ärzte 2009
NEU OP II
Die verbrannten Hautareale sollten möglichst schnell lokal gekühlt werden. Cave: Unterkühlung. Deshalb nicht zu kaltes Wasser zu großflächig verwenden, genügend Flüssigkeit verabreichen, an Tetanusschutz denken. Als Schmerzmedikament eignet sich Ketamin.

Neurologische Notfälle
Besonders in Indien erlebte ich als neurologischen Notfall häufig epileptische Anfälle, die in einem Status Epilepticus endeten. Diese Anfälle waren sehr oft, neben Tuberkulose, durch Neurozystizerkose verursacht. So wie Tuberkulome können die Zysten des Schweinebandwurmes, Taenia solium, je nach Lokalisation im ZNS unterschiedlichste Symptome provozieren. Dabei sind viele Menschen in Ländern wie Indien – schon allein kulturell und religiös bedingt – Vegetarier und kommen nie mit
Schweinefleisch in Berührung … Der Grund liegt oft in einer Düngung der Felder mit menschlichen Fäzes oder in der Fütterung von Tieren.
Bei jedem Anfall, der über mehrere Minuten dauert, empfiehlt es sich, immer zuerst den Blutzucker zu messen. Als Medikamente eignen sich:
• 1. W.: Lorazepam (Temesta, Tavor):










2-4-8 mg lgs. i. v.
• 2. W.: Midazolam (Dormicum):
2-7,5-10 mg
• Falls damit keine Wirkung erzielt wird: nach 5-10 Minuten WH (2-3 x). Bei der Therapie ist zu beachten, dass bei Verwendung des Hypnotikums Propofol (1 %!) die Dosierung 2 mg/kg KG i. v. im Grunde bereits die Indikation zur Intubation darstellt.



Differentialdiagnostisch sind in erster Linie eine Synkope oder ein psychogener Anfall abzugrenzen. Dabei ist die Synkope in der Regel kürzer und mit
NACHBERICHT
einem Gefühl der Leichtigkeit („Kopfleere“), mit Tunnelblick und Leiserhören verbunden. Der Patient ist relativ rasch reorientiert. Beim epileptischen Anfall hingegen werden aus der Magengegend aufsteigende Wärme/Übelkeit sowie Sensibilitätsstörungen halbseitig bzw. im Gesicht beschrieben. Der Patient ist langsam reorientiert, oft kommt es zu einem Nachschlafen. Der psychogene Anfall dauert meist länger als fünf Minuten. Merke: Generalisierte Anfälle stehen oft am Beginn eines Herz-Kreislauf-Stillstandes.









Vorschau: Serie Notfälle in den Tropen, Teil 2: Von Tauch- und Ertrinkungsunfällen über Verletzungen durch Tiere und Nahrungsgifte bis hin zu den Herausforderungen bei sozialen Einsätzen.


ENCEPUR® KANN BEIM SCHUTZ VOR FRÜHSOMMERMENINGOENZEPHALITIS (FSME) HELFEN!
ENCEPUR® BIETET VERSCHIEDENE IMPFSCHEMATA, UM INDIVIDUELLEN UND FAMILIÄREN BEDÜRFNISSEN GERECHT ZU WERDEN.1,2
Encepur® Kinder (0,25 ml) ist zur aktiven Immunisierung von Kindern ab dem vollendeten 1. Lebensjahr und bis zum Ende des 12. Lebensjahrs gegen FrühsommerMeningoenzephalitis (FSME) indiziert.1
Encepur® Erwachsene (0,5 ml) ist zur aktiven Immunisierung von Personen ab 12 Jahren gegen Frühsommer-Meningoenzephalitis (FSME) indiziert.2



Hausärzt:in medizinisch
1) Aktuelle Fachinformation für Encepur® Kinder. 2) Aktuelle Fachinformation für Encepur® Erwachsene. Fachkurzinformation auf Seite 48. AT-EC-2300006 | 03-Feb-2023
<
Der Gastautor war Vortragender zum Thema „Notfälle in den Tropen“ bei der 25. Linzer Reisemedizinischen Tagung, 14. bis 16. April 2023, Landeskulturzentrum Ursulinenhof.
Schluss mit dem Mauerblümchen-Dasein
Das war der Hausärzt:in Dialogtag 2023 in Linz zum Thema Schmerzmedizin

„Moderne Schmerzmedizin – Möglichkeiten und Grenzen“ lautete der Titel des heurigen Hausärzt:in Dialogtags, der am 3. Juni im Ordensklinikum Linz stattgefunden hat.
Unter dem Motto „Hausärzt:in trifft Kliniker:in“ stand die mit sieben DFPPunkten approbierte Fortbildung ganz im Zeichen von Dialog und Austausch. Kliniknah und praxisrelevant berichteten die Vortragenden über die Herausforderungen der Schmerzmedizin im niedergelassenen und ambulanten Bereich – angefangen vom chronischen Schmerz über Geriatrie und Palliativmedizin bis hin zu Medikationsmanagement und Polypharmazie und zuletzt
zur Schmerzbehandlung bei Säuglingen, Babys und Kindern. Organisiert wurde der Tag vom Fachmagazin Hausärzt:in in Kooperation mit dem Ordensklinikum Linz und der Oberösterreichischen Gesellschaft für Allgemein- und Familienmedizin (OBGAM). Kernstück der Veranstaltung war eine Podiumsdiskussion, bei der Expert:innen aus Medizin, Politik und Interessensvertretung zum Thema „Ambulante Schmerztherapie heute: Was tun gegen Lücken in der Versorgung“ diskutierten. Besprochen wurde der Status quo der Schmerzmedizin in Österreich, wobei ein Fokus auf die Lage in Oberösterreich gerichtet wurde.
Die Moderation übernahm Schirmherr Dr. Florian Ardelt, Allgemeinmediziner in Marchtrenk (OÖ) und Präsident der OBGAM.
Status quo in Österreich
Volker Hartl, stv. Obmann des Dachverbands Selbsthilfe Oberösterreich, eröffnete die Diskussion aus Patient:innensicht. Zwar gäbe es deutliche Verbesserungen im Vergleich zur Situation vor 30 Jahren, dennoch sei hier reichlich Luft nach oben. Wartezeiten seien ein großes Thema, auch würden Rezepte für Medikamente ausgestellt, bei denen letztlich keine Erstattung erfolge,
14 Juni 2023 Hausärzt:in politisch © privat
>


15 Juni 2023 Hausärzt:in politisch Pfizer Corporation Austria GmbH Wien www.pfizer.at, www.pfizermed.at PP-FID-AUT-0016/01.2023 https://www.pfi.sr/was-ist-gentherapie Der Zugang ist ganz einfach über den QR-Code oder unter folgendem Link möglich: Wie funktioniert eine Gentherapie? Auf unserem Portal finden Sie viele Informationen zum Thema Gentherapie, darunter auch ein Mode of Action-Video, das sehr anschaulich erklärt, wie der AAV-basierte Gentransfer funktioniert. AAV, Adeno-assoziierte Viren
Hausärzt:in politisch
Therapien wiederum würden nicht wahrgenommen, weil sie nicht erstattet würden. Fazit: Die Erfahrungen, die Betroffene machen müssen, sind oftmals belastender als die Krankheit selbst. In dieselbe Kerbe schlägt Dr. Erwin Rebhandl, seit 40 Jahren Allgemeinmediziner in Haslach an der Mühl (OÖ). Die Medizin würde sich zwar laufend weiterentwickeln, nur was die Schmerzmedizin betrifft, trete man seit Jahrzehnten auf der Stelle. In Oberösterreich fehle es an ambulanten Strukturen, um eine multimodale Schmerztherapie anbieten zu können. Im niedergelassenen extramuralen Bereich gäbe es darüber hinaus auch zu wenige Kolleg:innen, die sich auf Schmerztherapie spezialisieren würden. „Ich halte es für wichtig, dass sich jede Ärzt:in im niedergelassenen Bereich mit Schmerztherapie auseinandersetzt und auch eine gewisse Grundtherapie anbieten kann“, so Dr. Rebhandl.
Schmerztherapie als Kassenleistung
Dr.in Birgit Kraft, Fachärztin für Anästhesie und Intensivmedizin, Fachbereich Versorgungsmanagement 3 der Österreichischen Gesundheitskasse, äußerte sich in ihrem Eingangsstatement zur Erstattung von Leistungen in der Schmerz-

therapie. Bevor man an Finanzierungen durch die Kasse denken könne, müsse die Schmerzmedizin in Österreich erst einmal im Strukturplan verankert werden. Im niedergelassenen Bereich gebe es darüber hinaus keinen Leistungskatalog für Schmerz. Dabei brauche es auch den politischen Willen und die Ärztekammer mit an Bord. „Denn: Wenn wir einen Katalog machen, dann müssen wir überlegen: Wer macht was? Was macht die Hausärzt:in? Was macht die Allgemeinmediziner:in mit Schmerzdiplom und welche Ärzt:innen sollen denn nun qualifizierte Behandlungsleistungen bei Schmerz weiterführend erbringen?“
Konsequenz eines solchen Katalogs wären jedoch Leistungsverschiebungen, die wiederum zu Missstimmungen führen könnten, warnt die Expertin und nennt ein Beispiel: 2014 hat die Wiener Gebietskrankenkasse für Infiltrations- und Infusionstherapie fast neun Millionen Euro ausgegeben, die an die Orthopäd:innen gehen. Würden sich hier die Zuständigkeiten verschieben, wäre zumindest auf der einen Seite Unzufriedenheit die Folge. Deshalb, so Dr.in Kraft, benötige man wirklich den Konsens für Veränderung – und die Länder an Bord.
Gleichzeitig brauche es neben dem niedergelassenen Bereich die Schmerzambulanzen. Was wiederum die Frage nach einer umfassenden Ausbildung auf den Plan bringe: In Österreich gebe es für Schmerzmedizin kein eigenes Curriculum, wie es in Deutschland
der Fall sei. Nichtsdestotrotz entwickle sich auch bei uns langsam der Gedanke, dass Schmerz nicht nur ein Symptom, sondern auch ein Krankheitsbild sei. Um eine flächendeckende Versorgung garantieren zu können, bedürfe es einer fundierten Schmerzausbildung.
Multimodale Schmerzzentren in OÖ geplant
Mag.a Dr.in Elisabeth Manhal, Bereichssprecherin für Gesundheit im niedergelassenen Bereich und Kultur, Land Oberösterreich, bestätigt zwar, dass es in der Schmerzmedizin Aufholbedarf gibt. Man wisse, dass für Schmerzpatient:innen keine zentrale Anlaufstelle und auch kein durchgehendes Behandlungskonzept vorhanden seien – dennoch sei Oberösterreich diesbezüglich schon etwas weiter als der Bundesschnitt. „Im Land gibt es bereits sechs Spitäler mit Schmerzambulanzen und in unserem Plan für 2025 ist die klar verbesserte Versorgung von Schmerzpatient:innen niedergeschrieben “ Geplant sei, multimodale Schmerzzentren zu errichten, und das sektorenübergreifend – also im intramuralen und extramuralen Bereich sowie in der Rehabilitation.
Attraktivierung der Schmerztherapie
Die Forderung von OA Dr. David Fuchs, Leiter der Abteilung Palliative Care am Ordensklinikum Linz, die Schmerzmedizin grundsätzlich attraktiver zu ma-
16 Juni 2023
© privat
Am Podium (v.l.n.r.): AM Dr. Erwin Rebhandl, Dr.in Elisabeth Manhal/Land OÖ, OA Dr. David Fuchs/OKL, Dr.in Birgit Kraft/ÖGK, Volker Hartl/ Selbsthilfe OÖ.
chen, stieß bei allen Expert:innen auf Zustimmung. „In meiner Wahrnehmung fristen die Schmerzambulanzen in Österreich ein ziemliches Mauerblümchendasein. Leider ist es eben nicht so, dass es da eine richtig coole Schmerzambulanz gibt, wo man als Anästhesist:in unbedingt arbeiten will“, so OA Fuchs. Also brauche es, wie seine Vorrednerin schon konstatiert hat, eine solide Ausbildung für die Jungmediziner:innen. „Und diese wiederum brauchen Strukturen, in denen sie ‚aufwachsen‘ können, um dann zu ‚hypertollen‘ Schmerzmediziner:innen zu werden“, sagt OA Fuchs und stellt die Frage in den Raum: „Wie kann man die Schmerztherapie oder auch die Palliative Care attraktiver machen?“ Denn: Derzeit heiße ambulant nun einmal „sporadisch“ – etwa jeden dritten Donnerstag eine Dreiviertelstunde lang. Das ist laut OA Fuchs nicht attraktiv genug. Einerseits seien hier die Spitäler aufgerufen, etwas zu tun. Gleichzeitig müssten die Länder Strukturen vorgeben. „Aber die können nur vorgeben: ‚Macht eine Schmerzambulanz!‘ Und (leider) nicht: ‚Macht eine extrem coole Schmerzambulanz!‘“


Eigenverantwortung von Patient:innen stärken
Dr.in Manhal bestätigt: „Ja, man kann als Land die Strukturen und Rahmenbedingungen zur Verfügung stellen, es braucht aber auch die Menschen, die dahinterstehen, die dafür brennen und das Fach attraktiv machen “ Klar sei auch, dass die demographische Entwicklung unumkehrbar sei. Es rückten weniger Menschen nach, die in den Arbeitsprozess einträten, viele Menschen, die älter würden, gingen in Pension und würden möglicherweise selbst behandlungsbedürftig. Deshalb müsse man als Land mit allen Ressourcen schonend umgehen. Nämlich nicht nur darauf schauen, dass der teuersten Struktur, also dem Spital, möglichst viel Aufwand erspart werde, sondern sich auch darauf konzentrieren, möglichst wenig „Nachschub“ zu produzieren. Gemeint sei damit, durch die Stärkung der Eigenverantwortung von Patient:innen das Gesundheitssystem zu entlasten und auch das Wissen um Prävention und um die Wirkung von Lebensstiländerungen zu fördern. Allgemein bekannt sei, dass Prävention wichtig, aber nicht populär sei, und das wolle man seitens des Landes vorantreiben.
Prävention statt Reparaturmedizin
Auch Dr.in Kraft betont seitens der Gesundheitskasse einen notwendigen Wandel, nämlich weg von der Reparaturmedizin hin zur Prävention. Auf die Schmerzmedizin umgelegt, müssten dann Hausärzt:innen die wesentlichen Weichensteller:innen sein, um ein Chronifizierungsrisiko, etwa bei Rückenschmerzen, zu erkennen und infolge schnell reagieren zu können. Vermutlich würde ein unkompliziertes Abfrage-Tool reichen, damit man die Patient:in richtig einschätzen und rechtzeitig abfangen könne, um eine multimodale Schmerztherapie einzuleiten – bevor Morphinäquivalente zum Einsatz kämen. Dazu seien jedoch bessere Strukturen notwendig. Einerseits müsse man die Hausärzt:innen in ihrer Eigenschaft
Wirksamkeit kann so einfach sein.
30 % Bis zu aller Metforminoder PPI-Patienten haben einen VitaminB12-Mangel.1,2
EMPFEHLEN SIE BEI VITAMIN-B12-MANGEL
VITAMIN B12 ANKERMANN ®
Als einziges Arzneimittel mit 1.000 μg pro Tablette kann Vitamin B12 Ankermann® einen Vitamin-B12-Mangel effektiv ausgleichen.3

Einziges orales Arzneimittel mit 1.000 μg
Wirksam und sicher seit 1989
Einfache Einnahme: nur 1× täglich


1 Chapman et al. Diabetes Metab 2016 Nov;42(5):316–327. 2 Hirschowitz et al. 2008 Aliment Pharmacol Ther 27, 1110–1121. 3 Eussen et al. Arch Intern Med 2005 May 23; 165 (10): 1167–1172.
BEZEICHNUNG DES ARZNEIMITTEL S: Vitamin B12 Ankermann® 1000 Mikrogramm überzogene Tabletten. QUALITATIVE UND QUANTITATIVE ZUSAMMENSETZUNG: 1 überzogene Tablette enthält Cyanocobalamin (Vitamin B12) 1000 Mikrogramm. Sonstige Bestandteile mit bekannter Wirkung: Lactose, Saccharose, Macrogolglycerolhydroxystearat. Liste der sonstigen Bestandteile: Povidon K 30, Stearinsäure, Montanglycolwachs, LactoseMonohydrat, Saccharose, Gummi arabicum, Talkum, Calciumcarbonat, Titandioxid, weißer Ton, Macrogol 6000, Macrogolglycerolhydroxystearat, Natriumdodecylsulfat, Croscarmellose-Natrium, Hypromellose, Hydroxypropylcellulose, mittelkettige Triglyceride. ANWENDUNGSGEBIET: Therapie eines Vitamin B12-Mangels. GEGENANZEIGEN: Überempfindlichkeit gegen den Wirkstoff, oder einen der genannten sonstigen Bestandteile. Vitamin B12 Ankermann® 1000 Mikrogramm überzogene Tabletten dürfen bei Patienten nicht angewendet werden, die sich einer Cyanid-Entgiftung unterziehen müssen (z. B. Patienten mit einer Tabak-bedingten Amblyopie). In diesen Fällen muss ein anderes Cobalamin-Derivat verabreicht werden. Patienten mit B12-Mangel, bei denen das Risiko einer Leberschen Optikusatrophie besteht, dürfen zur Behandlung eines B12-Mangels nicht mit Cyanocobalamin behandelt werden. PHARMAKOTHERAPEUTISCHE GRUPPE: Antianämika, Vitamin B12 und Folsäure, Vitamin B12 (Cyanocobalamin und Analoga), ATC-Code: B03BA01. INHABER DER ZULASSUNG: Wörwag Pharma GmbH & Co. KG, Flugfeld-Allee 24, 71034 Böblingen, Deutschland. REZEPTPFLICHT/

APOTHEKENPFLICHT: Rezept- und apothekenpflichtig. Weitere Angaben zu den Abschnitten Dosierung u. Art d. Anwendung, besondere Warnhinweise und Vorsichtsmaßnahmen für die Anwendung, Wechselwirkung m. and. Arzneimitteln u. sonstige Wechselwirkungen, Fertilität, Schwangerschaft und Stillzeit sowie Nebenwirkungen entnehmen Sie bitte der veröffentlichten Fachinformation. STAND DER INFORMATION: 01/2022

17 Juni 2023
>
Hausärzt:in politisch
als Weichensteller:innen stärken, andererseits brauche es nachfolgende Strukturen, sprich Patient:innenpfade, wo die Allgemeinmediziner:innen die Patient:innen hinschicken könnten. Hier würden erste Pilotprojekte entwickelt, wobei die jeweilige Versorgungslandschaft berücksichtigt werden müsse. Schließlich könne man nicht jedes Modell überall gleich ausrollen.
Vernetzung aller Stakeholder wichtig
Aus Sicht der Selbsthilfe unterstreicht Volker Hartl die Bedeutung der Vernetzung aller Beteiligten. „Wir sehen, dass in jenen Gebieten, wo Therapeut:innen und Ärzt:innen mit organisierten Selbsthilfegruppen zusammenarbeiten, zwischenmenschlich alles funktioniert und eine gegenseitige Akzeptanz vorhanden ist. Dynamiken entstehen, die Heilungsprozesse sehr stark verkürzen können.“ Innerhalb der Selbsthilfegruppen funktioniere der Wissensaustausch sehr gut. Um einen Know-how-Transfer zu gewährleisten, wäre schließlich eine offene Kommunikation zwischen Medizin, Krankenhäusern und Selbsthilfegruppen wünschenswert.
Multiprofessionelle Zusammenarbeit
Über eine gute Vernetzung verfügt Dr. Rebhandl, der seit 40 Jahren in der All-
gemeinmedizin „beheimatet“ ist, vor fünf Jahren die Primärversorgungseinheit in Haslach mitbegründet hat und dadurch auf mehr personelle Strukturen zurückgreifen kann. Im Gesundheitszentrum habe man die Möglichkeit, für Schmerzpatient:innen unter Einbeziehung aller notwendigen therapeutischen Berufe ein gemeinsames Therapiekonzept entwickeln zu können. „Wir haben die Physiotherapie im Haus, wir haben die Ergotherapie, wir haben die Pflege und wenn wir auf der psychischen Ebene arbeiten wollen, haben wir auch eine Psychotherapeutin im Haus. Falls Ernährungsfragen aufkommen, ist eine Diätologin im Einsatz. Und das kostenfrei für Patient:innen, was ja sonst in der Sozialversicherung nicht gewährleistet ist. Kurz gesagt: Wir haben sehr viele Ressourcen, auf die wir zugreifen können. In Teambesprechungen entwickeln wir umfassende Konzepte, die ambulant umgesetzt werden können“, so Dr. Rebhandl. „Schwierig wird es“, räumt er ein, „wenn unsere Möglichkeiten überschritten werden und wir die Patient:in weiterschicken müssen “ Da gebe es wenig Spielraum und eine Wartezeit von bis zu vier Monaten. „Ich wünsche mir auch in Oberösterreich eine Einrichtung, wie sie es in Klagen-
DIE EXPERT:INNEN DER PODIUMSDISKUSSION
Der Schirmherr des Kongresses moderierte die Podiumsdiskussion und berichtete in seinem Vortrag über seine Erfahrungen aus der Geriartrie und der Palliativmedizin in der Hausarztpraxis.
„Jungmediziner:innen brauchen Strukturen, in denen sie, aufwachsen' können, um dann zu ,hypertollen' Schmerzmedizinern zu werden."
„Die Erfahrungen, die Betroffene machen müssen, sind oftmals belastender, als die Krankheit selbst.“
08:45 UHR: BEGRÜSSUNG
09:00 - 10:00 UHR: VORTRAG Chronischer Schmerz: Eine Herausforderung
OÄ Dr.in Alexandra Bachl Anästhesiologie und Intensivmedizin, Ordensklinikum Linz Barmherzige Schwestern
10:00 – 11:00 UHR: VORTRAG Geriatrie & Palliativmedizin: Schmerztherapie ist Teamarbeit
Dr. Florian Ardelt Allgemeinmediziner, Präsident der OBGAM



OA Dr. David Fuchs Leitung Palliative Care, Ordensklinikum Linz Barmherzige Schwestern DGKP Martin Rothe, MSc Abteilung 2D OrdensklinikumPalliativ, Linz Barmherzige Schwestern
11:30 - 12:45 UHR: MITTAGSPAUSE
12:45 - 14:15 UHR: PODIUMSDISKUSSION
Ambulante Schmerztherapie heute: Was tun gegen Lücken in der Versorgung?
OA Dr. David Fuchs Leitung Palliative Care, Ordensklinikum Barmherzige Schwestern Linz Volker Hartl Stv. Obmann und Kassier, Selbsthilfe Oberösterreich Dr.in Birgit Kraft Fachärztin für Anästhesie und Intensivmedizin, Fach- bereich Versorgungsmanagement 3, Österreichische Gesundheitskasse Mag.a Dr.in Elisabeth Manhal Bereichssprecherin für Gesundheit im nieder- gelassenen Bereich und Kultur, Land Oberösterreich Dr. Erwin Rebhandl Allgemeinmediziner, ehemaliger Präsident der OBGAM
14:15 - 14:45 UHR: PAUSE
14:45 - 15:45 UHR: VORTRAG
Klinische Pharmazie:
Medikationsmanagement und Polypharmazie
Univ.-Prof. Dr. Erika Zelko, PhD Leitung Institut für Allgemeinmedizin, Johannes Kepler Universität Linz Mag. pharm. Elisabeth Steiner aHPh Klinische Pharmazeutin, Apotheke, Ordensklinikum Linz Barmherzige Schwestern


15:45 - 16:45 UHR: VORTRAG
Pädiatrie: Kleiner Mensch, großer Schmerz
OÄ Dr. Elke Pernegger Abteilung für Kinderheilkunde & Neonatologie, Krankenhaus Barmherzige Schwestern Ried & Abteilung für Kinder- und Jugendheilkunde, Ordensklinikum Linz Barmherzige Schwestern
16:45 - 17:30 UHR: AUSTAUSCH & DISKUSSION Programmänderungen vorbehalten
Mit freundlicher Unterstützung von:
furt beim Kollegen Likar gibt (Anm. der Red.: Prim. Univ.-Prof. Dr. Rudolf Likar, MSc). Ich habe schon Patient:innen nach Kärnten geschickt, die drei bis vier Wochen im Hotel gewohnt und ambulant eine intensive Schmerztherapie wahrgenommen haben – mit guten Langzeiterfolgen. Ein Fortschritt für alle Beteiligten.“
©
Dr.in Birgit Kraft Fachärztin für Anästhesie und Intensivmedizin, Fachbereich Versorgungsmanagement 3 der Österreichischen Gesundheitskasse
„Man braucht den Konsens für Veränderung, und die Länder an Bord.“
Mag.a Dr.in Elisabeth Manhal Bereichssprecherin für Gesundheit im niedergelassenen Bereich und Kultur, Land Oberösterreich
„Es braucht Menschen, die dahinterstehen, die dafür brennen und die Schmerzmedizin attraktiv machen.“
Dr. Erwin Rebhandl Allgemeinmediziner, Gesundheitszentrum Haslach an der Mühl
„Ich halte es für wichtig, dass sich jede Ärzt:in im niedergelassenen Bereich mit Schmerztherapie auseinandersetzt und auch eine gewisse Grundtherapie anbieten kann.“

18 Juni
2023
Mag.a Ulrike Krestel
Dr. Florian Ardelt Allgemeinmediziner in Marchtrenk (OÖ) und Präsident der OBGAM
© privat
Dr. David Fuchs Leiter der Palliative Care am Ordensklinikum Linz
© Ordensklinikum Linz
Volker Hartl stv. Obmann der Selbsthilfe Oberösterreich
© Selbsthilfe OÖ
© ÖGK
© ÖAAB OÖ
privat PROGRAMM VERANSTALTUNGSORT Gesundheitspark Barmherzige Schwestern Linz Seminarzentrum 1. OG Herrenstraße 54, 4020 Linz
7 DFP-Punkte gab es für die spannenden Vorträge samt Fallbeispielen.
Prävention im Mittelpunkt
Beim 29. ÖSG-Kongress 2023 in Villach

Eine lege artis durchgeführte Therapie von (chronischen) Schmerzen ermöglicht es Betroffenen, ihren Alltag zu bewältigen und am gesellschaftlichen Leben teilzunehmen. Besser als eine Therapie ist allerdings immer die Verhinderung von Schmerzzuständen. Deshalb widmete sich der 29. Kongress der Österreichischen Schmerzgesellschaft (ÖSG), der heuer von 11. bis 13. Mai in Villach stattfand, dem Thema Schmerzprävention.

Neben Keynote-Speaker Prof. Dr. Konrad Paul Liessmann, der einen Vortrag über „Die Lust und ihre Qualen“ hielt, bot ein umfassendes wissenschaftliches Programm rund um Prävention, Diagnostik und Therapie den Besucher:innen Informationen aus dem gesamten Bereich der Schmerzmedizin. So wurde der verantwortungsvolle Einsatz von Opioiden ebenso diskutiert wie der neuropathische Schmerz und viele andere Themen. Zeitgleich mit dem Kongress ging am 11. Mai auch ein Pflegesymposium über die Bühne: „Die Pflege im Rahmen einer Schmerzbehandlung hat einen sehr hohen Stellenwert“, erklärte ÖSG-Präsidentin OÄ Dr.in Waltraud Stromer diesbezüglich. „Dem wollten wir mit unserem Pflegesymposium Rechnung tragen “
Gutes Feedback




„Mit unserem Kongress wollen wir all jenen Kolleg:innen, die täglich Patient:innen behandeln, die unter Schmerzen leiden, rezente Studiendaten sowie diagnostische und therapeutische Möglichkeiten näherbringen“, hielt Kongresspräsident Univ.-Prof. Dr. Rudolf Likar fest. „Insbesondere der Austausch unter Kolleg:innen ist uns wichtig. Außerdem haben wir uns zum Ziel gesetzt, viele junge Ärzt:innen anzusprechen und für die Schmerzmedizin zu begeistern.“
Die Teilnahme war vor Ort und online möglich. Viele der an die 450 Teilnehmenden aus ganz Österreich entschieden sich, zwecks des Austausches vor Ort zu sein. Ein Novum heuer waren etwa die Draugespräche. Laut den Gastgebern kamen diese Diskussionsrunden mit renommierten Schmerzexpert:innen sehr gut an. Sie sollen daher beim 30. ÖSG-Kongress vom 7. bis 8. Juni 2024 in Villach wieder ein Fixpunkt sein.
©
ÖSG
PA/KaM
NACHBERICHT 29. Wissenschaftlicher Kongress der Österreichischen Schmerzgesellschaft, 11. bis 13. Mai 2023, Congress
Gebro Pharma Dex ibuprofen analgetisch antipyretisch antiphlogistisch * Seractil ® Filmtabletten in der Green Box: 200 mg: 30 und 50 Stk. 300 mg: 10, 30 und 50 Stk. 400 mg forte: 10 und 50 St k. Seractil® die Kraft gegen Schmerz und Entzündung Dexibuprofen * Seractil ® akut 400 mg Pulver auch zum Trinken GPB.SER 220215 Fachkurzinformation siehe Seite 48
Center Villach.
„Sportverletzungen sind im Sommer häufig“

Patient:innen mit Distorsion oder Kontusionen in der hausärztlichen Praxis
Wie ist das optimale Vorgehen, welche Therapieoptionen bieten sich an?
Als Erste-Hilfe-Maßnahme sollte man die verletzte Region ruhig stellen, hochlagern, kühlen und – das wird oftmals vergessen – komprimieren. Ziel dieser Maßnahmen für die ersten Minuten bzw. für bis zu 48 Stunden nach der Verletzung ist, Einblutungen ins Gewebe und Entzündungen möglichst hintanzuhalten. Die therapeutischen Mittel sind dann insbesondere davon abhängig, wie stark das Trauma und somit die Verletzungsfolgen sind.
Beschleunigung des Abtransportes der Flüssigkeit durch manuelle Lymphdrainage eine sehr effiziente Maßnahme. Ebenso Querfriktionen an den verletzten Bändern sowie Faszientherapien. Bei länger dauernder unzureichender Belastbarkeit des betroffenen Gelenks sind aufbauende Übungen im Sinne einer medizinischen Trainingstherapie sinnvoll bzw. eigentlich obligater Teil der Behandlung.
Was, wenn die Patient:innen ungeduldig sind, weil sich nicht schnell genug eine Besserung einstellt?
HAUSÄRZT:IN: Welche Bedeutung kommt Prellungen und Verstauchungen generell und in der Allgemeinmedizin bzw. der Sportmedizin zu?
Dr. ECKER: Sowohl Prellungen als auch Verstauchungen kommt in der Allgemein- und Sportmedizin schon allein aufgrund der Häufigkeit eine große Bedeutung zu. Prinzipiell handelt es sich dabei um zwei völlig unterschiedliche Verletzungen: Während Kontusionen durch stumpfe Gewalteinwirkung entstehen und das Gewebe unter der Haut mehr oder weniger schädigen, wird bei einer Distorsion ein Gelenk mit Gewalt über den physiologischen Bewegungsumfang hinausbewegt. Dadurch entstehen an den überdehnten Bändern und an den Gelenkkapseln Zerrungen bzw. kleine Einrisse.

Welche Herausforderungen ergeben sich im Kontext von Sportverletzungen in der Praxis?
Die Herausforderung in der Praxis ist –speziell bei Verstauchungen –, klinisch zu unterscheiden, ob eine weitere bildgebende Abklärung z. B. zum Ausschluss einer knöchernen Verletzung oder eines Bänderrisses mit drohender Gelenkinstabilität erforderlich ist oder nicht. Und dann sollten natürlich adäquate und sinnvolle therapeutische Schritte gesetzt werden …
Wann sollte unbedingt eine Überweisung an Fachärzt:innen bzw. in eine Ambulanz erfolgen? Ich überweise dann an einen radiologischen Facharzt bzw. in eine unfallchirurgische Ambulanz, wenn eine knöcherne Beteiligung nicht auszuschließen ist bzw. wenn – im Falle einer Distorsion – gröbere Verletzungen der Gelenke selbst oder gelenknaher Strukturen nicht auszuschließen sind. Eine zeitnahe MRT ist nun mal in einem Krankenhaus bei Notwendigkeit schneller verfügbar als bei niedergelassenen Radiologen.
Welche Rolle kommt der Zusammenarbeit mit anderen Berufsgruppen wie Physiotherapeut:innen zu? Einen guten Teil der Behandlung biete ich selbst mittels – je nach Verfügbarkeit – unterschiedlicher physikalischer Maßnahmen an. Bei stärkerer Schwellung im Bereich der verletzten Region ist eine
Dann erkläre ich der Patientin/dem Patienten die Physiologie – vor allem die Phasen und die Dauer – der Gewebeheilung und biete möglicherweise weitere therapeutische Optionen an. Manchmal muss ich auch später die Indikation zu einer MRT-Abklärung stellen.
Ihr abschließender Rat an die Kolleg:innen in der Praxis?
Wenn man eine Hausarztpraxis führt bzw. vorhat, als Allgemeinmediziner in der Primärversorgung tätig zu sein, sollte man sich unbedingt möglichst intensiv mit orthopädischen und unfallchirurgischen Erkrankungen bzw. Verletzungen auseinandersetzen und eine Ausbildung in diesem Bereich absolvieren. Ein guter Teil der Patientinnen und Patienten kommt mit solchen Problemstellungen in die Praxis.
Hausärzt:in medizinisch 20 Juni 2023
© privat
Dr. Ronald Ecker, Arzt für Allgemeinund Sportmedizin in Marchtrenk (OÖ), im Gespräch.
© shutterstock.com/Ground Picture
Das Interview führte Mag.a Karin Martin.
zieht Entzündungen aus der Haut.
Neue Untersuchungsergebnisse belegen: Dunkles
ICHTHYOL® bekämpft Bakterien inklusive MRSA.1
MRSA-Infektionen sind eine häufige Ursache für Hautabszesse. 2 Besonders bei resistenten Keimen ist eine frühzeitige effektive Behandlung von entscheidender Bedeutung.
ICHTHYOL ® , chemisch Ammoniumbituminosulfonat, ist ein einzigartiger Wirkstoff, der aus natürlichem Schieferöl gewonnen wird.
ICHTHYOL ® besitzt eine nachgewiesene Wirksamkeit gegen die häufigsten hautpathogenen Keime.
Jetzt konnte auch die antibakterielle Wirkung gegen Methicillin-resistente Staphylococcus aureus-Stämme (MRSA) belegt werden. 1
Hierzu wurden die minimalen Hemmkonzentrationen (MHK) von ICHTHYOL ® bei MRSA in-vitro untersucht. Die MHK entspricht dabei der niedrigsten Wirkstoffkonzentration, die zu einer Hemmung des Bakterienwachstums führt. Die ermittelte MHK liegt bei 0,7 %. Alle ICHTHOLAN® Zugsalben übertreffen diese MHK-Konzentration um mehr als das Zehnfache.1
ICHTHYOL® fördert die Abszessreifung und Entleerung und ist durch die zusätzliche antibakterielle Wirkung für die Therapie von Abszessen geeignet, insbesondere da keine Resistenzen gegen den Wirkstoff zu erwarten sind.1

Antientzündliche Wirkung
ICHTHOLAN® hemmt zwei wichtige Enzyme des Arachidonsäure-Metabolismus: 5-Lipoxygenase (5-LOX) und Cyclooxygenase (COX). Entzündungsmediatoren, die aus diesem Stoffwechselweg entstehen, wie Prostaglandine und Leukotrien B4, werden vermindert.3
Effektive Zugwirkung
Durch ICHTHOLAN® wird die Hautbarriere aufgelockert. Bei einem Abszess kann selbst tiefliegender Eiter dadurch schneller abfließen und die Haut abheilen.4
Schmerzlindernd
ICHTHOLAN® 50 % wirkt durch die nachgewiesene COX-Hemmung nicht nur entzündungshemmend, sondern auch schmerzlindernd.4
ICHTHOLAN® – Verschreiben Sie je nach Tiefe der Entzündung die passende Wirkstärke:

ICHTH OLAN ®
Je tiefer der entzündliche Prozess im Gewebe liegt, desto höher ist die empfohlene Wirkstoffkonzentration.
Kassenfrei
- Grüne Box
1110 Wien Stand der Information: Mai 2023, ICH_2023_003
ICHTHOLAN®
1 Sethmann A. Update zur antibiotischen Behandlung unkomplizierter Hautabszesse. Evid Self Med 2022;2:220036. Epub 2022 Jan 31.
2 Singer, A.J. and D.A. Talan, Management of Skin Abscesses in the Era of Methicillin-Resistant Staphylococcus aureus. 2014. 370(11): p. 1039-1047.
4 Fachinformation Ichtholan 50%. Stand der Information November 2013. Vertrieb in Österreich: Sanova Pharma GesmbH, Haidestraße 4,
3 Schewe, C., et al., Inhibitory effects of sulfonated shale oils (ammonium bituminosulphonates, Ichthyols) on enzymes of polyenoic fatty acid metabolism. Arch Dermatol
Res, 1994. 286(3-4): p. 137-41.
Wirkstoff: Ammoniumbituminosulfonat Zugsalbe in drei Wirkstärken ICHTHYOL®wirkt MRSAgegen 1 Fachkurzinformation siehe Seite 48
Univ.-Lekt. Dr. Piero Lercher, Sportarzt, Präventiv-, Arbeits- und Umweltmediziner in Wien.

Speziell in der Sommerzeit können auch die Ohren im Fokus der Sportmedizin stehen: Dürfen Personen mit einem
Cochlea-Implantat (CI) Sport treiben? Wann sollten HNO-Patientinnen und -Patienten von bestimmten Sportarten Abstand nehmen? Und was hat es mit dem Surfer-Ohr auf sich? Unter anderem diesen Fragen geht Univ.Lekt. Dr. Piero Lercher, Sportarzt, Präventiv-, Arbeits- und Umweltmediziner in Wien, im „Wordrap-Interview“ mit der Hausärzt:in nach.
Sportverletzungen der Ohren: Hier sind speziell Kampfsportarten zu nennen, bei denen als Resultat häufiger Verletzungen letztendlich das sogenannte Blumenkohlohr entsteht. Eine abstruse und derzeit populäre Sportart ist Slap Fighting, wo man sich gegenseitig ohne Abwehrreaktion bis zum Bewusstseinsverlust ohrfeigt. Hierbei kommt es sehr häufig zu Ohr-, Gehörgangs- und Trommelfellverletzungen. Weitere Ohrverletzungen
im Sport sind beispielsweise das Knalltrauma bei Sportschützen oder das Barotrauma beim Tauchen.

Patient:innen mit Cochlea-Implantat: Auch mit einem Cochlea-Implantat darf und soll man Sport treiben und körperlich aktiv sein. Unabhängig von der Sportart sollte man jedoch immer den Kopf und das Implantatsystem vor Stößen und Schlägen schützen. Schäden durch Feuchtigkeit oder durch Schweiß sollten vermieden werden, indem der Soundprozessor während des Gebrauchs geschützt und im Anschluss in ein spezielles Trocknungssystem gelegt wird. Wichtig ist, alle Anweisungen und Warnungen der jeweiligen Hersteller zu beachten.
Sporttreiben mit CI: Nutzern von Cochlea-Implantaten wird dringend von
Hausärzt:in medizinisch 22 Juni 2023
„Weder sich selbst noch andere gefährden“
© shutterstock.com/Rich Carey
WORDRAP über otologische Probleme im Zusammenhang mit Sport
© Andrea Hausmann
Sportarten abgeraten, bei denen es zu physischen Verletzungen, Druck oder Stößen am Kopf kommen kann oder diese unvermeidbar sind, beispielsweise Boxen, Rugby, Judo, Karate. Bei Sportarten, für die ein Helm benötigt wird, etwa Radfahren, Reiten, Segeln oder Skifahren, soll man sicherstellen, dass ein hochwertiger Helm verwendet wird, der bequem und einfach einstellbar ist.
Schwindel bei Anstrengung: Schwindel ist immer ein Warnsignal. Unabhängig von der Art des Schwindels (z. B. Drehschwindel, Schwankschwindel) ist bei Auftreten ein sofortiger Sportabbruch empfohlen. Schwindel darf keinesfalls bagatellisiert werden und erfordert immer eine umfassende ärztliche Abklärung.

Höhen- und Tauchsport: Das Um und Auf ist hier eine sportärztliche Freigabe nach einer umfassenden Höhenoder Tauchtauglichkeitsuntersuchung. Ein absolutes NoGo ist ein „Wischiwaschi“-Check bei unseriösen Anbietern, wie er oftmals vor Ort billig und leicht erhältlich angeboten wird. Man muss sich dessen bewusst sein, dass man im Falle eines gesundheitlichen Zwischenfalles nicht nur sich selbst, sondern auch die anderen gefährdet. Das gilt für den Orientierungsverlust und die dadurch bedingte Panikreaktion sowohl am Berg als auch beim Tauchen. Eine Tuben- oder Trommelfellproblematik verhindert zudem einen Druckausgleich und führt u. a. zu starken Schmerzen.
Otologische Kontraindikationen: Prinzipiell stellen akute Erkrankungen, fieberhafte Zustände und neu aufgetretene Schmerzen eine absolute Kontraindikation für körperliche Belastungen dar. Generelle otologische Kontraindikationen sind beispielsweise eine beidseitige hochgradige bzw. nicht therapierte Hörstörung, eine Otospongiose, eine Felsenbeinfraktur, eine ein- oder beidseitige Schädigung des Labyrinths, perilymphatische Fisteln oder ein unkompensiertes Defizit des Gleichgewichtsorgans. Bei Tubenoder Trommelfellproblemen wird von einem Aufenthalt in großen Höhen und vom Tauchsport abgeraten.
Otitis media: Eine Mittelohrentzündung bedarf immer einer ärztlichen Abklärung und Therapie. Eine Sportfreigabe sollte immer erst nach einer Heilung bzw. nach Sistieren der Symptomatik erfolgen.





Besondere Wetterverhältnisse: Eine vielfach noch unbeachtete und weitgehend unbekannte Problematik stellen Gehörgangsexostosen dar, die infolge exzessiver Exposition gegenüber Wasser und Wind entstehen. Diese Knochenneubildungen im äußeren Gehörgang werden auch SurferOhr genannt, treten aber beispielsweise auch beim Wakeboarden oder Segeln auf. Sie sind medizinisch behandlungsbedürftig und dürfen nicht bagatellisiert werden.








Das Wordrap-Interview führte Anna Schuster, BSc.


• Für Ki nd er ab 2 Ja hren

• Bei chronisch suppurativer Otitis media



• Bei Otitis externa mit vermuteter Trommelfellperforation oder Parazentese


Praktische

Badesaison GPB.OTA 200501 R Ot a n o l Ciprofloxacin-Ohrentropfen
Dosierung durch Einzeldosisbehältnis fr e i v on K o n s e ivr e r u sgn m i t t e l ohne Parabene
Fachkurzinformation siehe Seite 48
Vorankündigung
Samstag, 07. Oktober 2023, 08:30 - 17:00 Uhr

Hotel Savoyen, Rennweg 16, Wien 1030
Kosten


Mitglieder: 75 €
Nicht-Mitglieder: 95 €
Anmeldung

https://www.arztassistenz.at/fortbildung/ termine-im-ueberblick/bda-termine/ tagungen-kongresse/8-bda-kongress







6 BdA Fortbildungspunkte
BdA-KONGRESS WIEN

Personalisierte Medizin: Hintergrundwissen für die Ärzt:in-Assistenz




© shutterstock.com/ADragan
Laufende Nase ...
Eine Rhinorrhoe kann
Eine Rhinorrhoe ist für Betroffene äußerst unangenehm. Die unmittelbare Reaktion der Umwelt darauf: „Halt Abstand zu mir, ich will nicht kriegen, was du hast “ Man verbindet die „laufende Nase“ vorschnell mit einer Infektion der oberen Atemwege. Doch es gibt – abgesehen von viralen Infekten und Allergien – eine Vielzahl anderer Ursachen. Die vasomotorische Rhinitis z. B. ist ein chronischer, nicht allergischer und nicht infektiöser Schnupfen. Es kommt zu einem zeitweiligen Anschwellen von Gefäßen in der chronisch entzündeten Nasenschleimhaut, zu wässrigem Sekret und Niesen. Die Ätiologie ist unklar. Durch Lufttrockenheit scheint sich der Zustand zu verschlechtern. Die Beschwerden können durch verschiedene Reize wie starke Gerüche, Rauch, Staub, Temperatur- und Druckveränderungen ausgelöst bzw. verschlimmert werden. Die Rhinitis atrophicans ist eine fortschreitende Nasenerkrankung, die zur Atrophie und Sklerosierung der Nasenschleimhaut führt. Sie kann mit fortgeschrittenem Alter oder mit einer Granulomatose mit Polyangiitis in Zusammenhang stehen oder iatrogen induziert sein. Auch hier ist die Ätiologie nicht im Detail bekannt. Offenbar spielen bakterielle Infektionen des Öfteren mit. Unter älteren Menschen ist eine Nasenschleimhautatrophie verbreitet. Von einer Altersrhinitis spricht man generell ab 65 Jahren. Es gibt eine Vielzahl von Phänotypen. Bei der typischen „ A lterslaufnase“ tropft wässriges Sekret völlig unkontrolliert aus der Nase, verstärkt durch äußere Einflüsse wie Temperaturwechsel oder gewürzte Speisen. Häufig liegt dem Problem eine Dysbalance von Becherzellen, Bürstensaumzellen und submukösen Drüsen im Nasenepithel zugrunde.
Zwei wesentliche Strategien, um eine Rhinorrhoe zu stoppen, sind: das Weglassen dessen, was die Nase reizt, und der Einsatz von Medikamenten, welche die Entzündung und/oder die Bildung von Nasensekret reduzieren und die Symptome lindern.

PA/KaM
Bereits ab 6 Jahren
Literatur:
Van Egmond MMHT et al., Rhinology, 56(3):195-208, 2018. Klimek L, Allergogologie, Bd. 43, Ausg. 6, 2020.
RHINORRHOE: MÖGLICHE URSACHEN
unterschiedliche Ursachen haben © shutterstock.com/9nong

Allergien
Reaktion auf Reizstoffe in der Umgebung
Fremdkörper in der Nase
Nasenpolypen, Fehlbildungen oder Tumoren
Schwangerschaftsrhinitis
gustatorische Rhinitis
Rhinitis medicamentosa
Trauma oder chirurgischer Eingriff
alters- oder krankheitsbedingte Veränderungen der Nase bzw. Nasenschleimhaut
Ipratropiumbromid
Damit alles läuft, außer die Nase!
• Zur symptomatischen Behandlung von Rhinorrhoe bei allergischer und nicht-allergischer Rhinitis

• Kein Gewöhnungseffekt1

1 PRAC PSUR assessment report dated 28 September 2017; PSUSA/00001780/201701
Nasipral 0,3 mg/ml Nasenspray, Lösung. Qualitative und quantitative Zusammensetzung: 1 ml Nasenspray, Lösung enthält 0,3 mg Ipratropiumbromid (entspricht 0,31 mg Ipratropiumbromid 1 H2O). Ein Sprühstoß enthält 21 Mikrogramm Ipratropiumbromid (entsprechend 22 Mikrogramm Ipratropiumbromid 1 H2O). Enthält 17,5 Mikrogramm Benzalkoniumchlorid pro Sprühstoß entsprechend 0,25 mg/ml. Sonstige Bestandteile: Natriumchlorid, Benzalkoniumchlorid, Natriumedetat (Ph.Eur.), Salzsäure 36 %, Natriumhydroxid, gereinigtes Wasser. Anwendungsgebiete: Zur symptomatischen Behandlung von Rhinorrhoe bei allergischer und nicht-allergischer Rhinitis bei Erwachsenen, Jugendlichen und Kindern. ab 6 Jahren. Gegenanzeigen: Überempfindlichkeit gegen den Wirkstoff oder einen der sonstigen Bestandteile. Pharmakotherapeutische Gruppe: Dekongestiva und andere Rhinologika zur topischen Anwendung. ATC-Code: R01AX03. Packungsgrößen: 20 ml. Inhaber der Zulassung: INFECTOPHARM Arzneimittel und Consilium GmbH, Von-Humboldt-Str. 1, D-64646 Heppenheim. Rezept und apothekenpflichtig. Stand 05/2021. Weitere Angaben zu Warnhinweisen und Vorsichtsmaßnahmen für die Anwendung, Wechselwirkungen, Schwangerschaft und Stillzeit, Nebenwirkungen entnehmen Sie bitte der veröffentlichten Fachinformation.
Vertrieb: INFECTOPHARM · Arzneimittel und Consilium GmbH · Von-Humboldt-Straße 1 D-64646 Heppenheim. Kontakt: InfectoPharm Arzneimittel und Consilium GmbH · LeopoldUngar-Platz 2 /1. Stock / Stiege 2 · 1190 Wien · Tel.: 01/227 60 65-6060 · Fax: 01/227 60 65-6061 www.infectopharm.at · austria.kontakt@infectopharm.com

A8001925-02-1022
Rezeptstudie
Österreichischer Verschreibungsindex
Werden Sie Teil einer Studie zur Arzneimittelversorgung in Österreich – völlig anonym melden Sie einmal pro Quartal die Verschreibungen und Diagnosen einer Arbeitswoche über ein bedienerfreundliches Online Tool, auf das Sie völlig flexibel auch von Ihrem Tablet oder Smartphone zugreifen können.

FÜR WEITERE FRAGEN:
+43 (0) 664 8000 2237
Alexa Ladinser
alexa.ladinser@iqvia.com
+43 (0) 664 8000 2237
Lidia Wojtkowska
medicalindex@iqvia.com
0800 677 026 (kostenlos)
120 €
Weltweite Studie zu indikationsbezogenen Verordnungen!
Flexibler Zugriff auf ein bedienerfreundliches Online-Tool.
Bis zu 120 € pro Stunde Aufwandsvergütung
26 Juni 2023
Hier scannen um sich zur Teilnahme zu registrieren.
weltweit
anonym
Sichere und anonyme Datenübermittlung 1x/Quartal. flexibel


DIALOG Harnwegsinfekte in den Griff bekommen Im Urlaub brennt’s
Neue Technologien in der Diagnose Brustkrebsvorsorge © shutterstock.com/Olivia Lunar
Sommer ohne Sorgen GYNÄKOLOGIE / UROLOGIE
Im Urlaub brennt‘s
Die Risikofaktoren für eine Zystitis sind umfangreich. Zu ihnen zählen etwa falsches Miktionsverhalten, geringe Trinkmenge, anatomische Verhältnisse wie Stenosen oder funktionelle Einschränkungen (z. B. durch einen vesikoureteralen Reflux), Diabetes mellitus, vorangegangene Harnwegsinfektionen, rezente Antibiotikaeinnahme und vermehrte sexuelle Aktivität. Im Sommer begünstigen häufig noch Badetage, mangelhafte hygienische Bedingungen in WC-Anlagen und Reisestress einen Harnwegsinfekt. Für Personen, die zu Zystitis neigen, stellt die Urlaubszeit also durchaus eine Herausforderung dar.

Gruber, Abteilung für Urologie, Klinikum Wels-Grieskirchen. Dabei unterstützen können zum Beispiel einfache Maßnahmen wie eine Erhöhung der Trinkmenge oder die Einnahme von Phytotherapeutika. Sie sollten bereits bei den ersten Anzeichen einer Zystitis angewendet werden. Als Durchspülungstherapie eignen sich Teezubereitungen aus diuretisch wirksamen Pflanzen, beispielsweise aus Liebstöckelwurzel, Birkenoder Brennnesselblättern. Darüber hinaus haben sich Präparate mit Harnwegsdesinfizientien wie Bärentraubenblättern, Rosmarin, Liebstöckel und Tausendgüldenkraut sowie den senfölhaltigen Drogen Meerrettich und Kapuzinerkresse bewährt. „Bessern sich die Beschwerden allerdings nicht innerhalb von ein bis zwei Tagen oder verschlechtern sie sich, soll ein Antibiotikum gegeben werden. Bei einer Pyelonephritis-Vorgeschichte würde ich gleich primär eine Antibiose verschreiben“, erläutert OÄ Gruber.
EXPERTIN:
OÄ Dr.in Manuela Gruber Abteilung für Urologie, Klinikum Wels-Grieskirchen

etwa ältere oder immunsupprimierte Menschen. „ Auch Anzeichen eines aufsteigenden Infekts wie Flankenschmerzen oder Fieber erfordern eine antibiotische Therapie. Empfohlen wird dann außerdem eine Sonographie, um eine zu behebende Harnstauung auszuschließen“, betont die Urologin. Harnwegsinfekte bei Männern sind in der Regel als kompliziert einzustufen, weil die Gefahr einer Prostatitis oder Epididymitis besteht. Neben einer raschen und ausreichend langen antibiotischen Behandlung sollte eine urologische Abklärung erfolgen. Ein Antibiogramm zu veranlassen, empfiehlt OÄ Gruber beispielsweise bei Verdacht auf Pyelonephritis oder Harnwegsinfektion in der Schwangerschaft sowie bei rezidivierenden und persistierenden Infekten bzw. Beschwerden.
Individualisierte Prävention
Kompliziert versus unkompliziert
„Eine unkomplizierte Zystitis heilt oft von selbst aus“, weiß OÄ Dr.in Manuela
Im Falle komplizierter Infektionen ist zumeist eine Antibiotikatherapie indiziert. Das betrifft Personen mit Risikofaktoren für einen schweren Verlauf oder Folgeschäden (siehe Infobox),
Ab drei Zystitiden pro Jahr und nach schweren oberen Harnwegsinfekten sollten Betroffene laut der Urologin fachärztlich abgeklärt werden, um ihnen spezifische präventive Maßnahmen vorschlagen zu können. Hierfür
28 Juni 2023 Hausärzt:in DIALOG Gyn/Uro
©
Klinikum Wels-Grieskirchen / Nik Fleischmann
©
shutterstock.com/220 Selfmade studio
Auch bei erhöhtem Risiko Harnwegsinfekte in den Griff bekommen
„Ab drei Zystitiden pro Jahr und nach schweren oberen Harnwegsinfekten sollten Betroffene fachärztlich abgeklärt werden.“
werden u. a. eine Harnfluss- und Restharnmessung, ein Ultraschall, eventuell eine Blasenspiegelung und eine Harnröhrenuntersuchung durchgeführt sowie ein Miktionstagebuch empfohlen. „ Für die Langzeitprävention gibt es zahlreiche Ansätze“, macht OÄ Gruber aufmerksam. Dazu zählen nach der Expertin beispielsweise:
• Verhaltensmaßnahmen wie eine ausreichende Flüssigkeitszufuhr von mind. 1,5 l/Tag, eine regelmäßige Miktion, die Blasenentleerung nach dem Geschlechtsverkehr oder nach dem Baden und richtiges Miktionieren – Stichwort: Nicht pressen!
• Harnansäuerung, z. B. mit Apfelessig – pur oder verdünnt, Cranberrykapseln, L-Methionin
• Nahrungsergänzung durch Kräuteressenzen, D-Mannose
• Hyaluronsäurepräparate (oral oder intravesikal)



• topische Hormone (postmenopausal)
• niedrig dosierte antibiotische Dauerprophylaxe oder Postexpositionsprophylaxe

• Immuntherapeutika, etwa in Form einer Schluckimpfung
Welche Strategie für wen am besten passt, gelte es herauszufinden, unterstreicht die Urologin.
Reisevorbereitung
Anfällige Personen sollten bestimmte Arzneimittel vorsorglich auf eine Reise mitnehmen. „ Entzündungshemmende Analgetika sind nicht nur bei Harnwegsinfekten hilfreich – sie sollten generell in keiner Reiseapotheke fehlen“, erklärt OÄ Gruber. Außerdem sei ein harngängiges Notfallantibiotikum mitzuführen, z. B. FosfomycinTrometamol, Pivmecillinam oder Nitrofurantoin, so die Expertin. Die Patientinnen und Patienten sollten wissen, welche Beschwerden eine medizinische Konsultation im Urlaubsland erfordern. „ Jedenfalls ist bei anhaltenden oder nicht beherrschbaren Schmerzen und bei Fieber, darüber hinaus im Falle einer starken Makrohämaturie mit Koagelabgängen eine ärztliche Behandlung angezeig t“, gibt OÄ Gruber abschließend zu bedenken.
 Anna Schuster, BSc
Anna Schuster, BSc
IM ÜBERBLICK
Risikofaktoren für einen komplizierten Verlauf
alle HWI bei Kindern, Männern, Schwangeren
funktionelle oder anatomische Besonderheiten, Z. n. OP
Immunsuppression
Fieber, Flankenschmerz
urologische/renale Erkrankung, Nierensteine
innerhalb der letzten zwei Wochen:
• Anlage eines Urinkatheters
• Entlassung aus dem Krankenhaus oder Pflegeheim
• Antibiotikatherapie in den letzten zwei Wochen
Quelle: S3-Leitlinie Brennen beim Wasserlassen, AWMF-Register-Nr. 053-001.
„Nicht immer sind Keime im Spiel”
Univ.-Prof.in Dr.in Doris Maria Gruber, Gynäkologin in Wien, im Gespräch über das Krankheitsbild der Zystitis in unterschiedlichen Lebensphasen

HAUSÄRZT:IN: Harnwegsinfekte treten vermehrt ab der Pubertät auf. Warum?
Prof.in GRUBER: Sobald die hormonelle Situation sich im weiblichen Körper merklich verändert, machen Mädchen und junge Frauen vermehrt mit dem Krankheitsbild der Zystitis Bekanntschaft. Die Pubertät als Zeit des hormonellen Umorganisierens erstreckt sich ja in der Regel über mehrere Jahre. Unabhängig davon, ob schon ein Geschlechtsverkehr stattgefunden hat oder nicht, kann sich da mal der pH-Wert der Scheide verändern, es können sich dadurch in der Umgebung vorhandene Bakterien unangemessen vermehren ... So kann es zu einer vaginalen Infektion oder einer Zystitis kommen, ohne dass damit das Einführen von Keimen einhergeht. Auch Hitze/Kälte oder die Ernährung und Stress spielen oft mit.
Kinder sind kaum betroffen?
Das stimmt. Die Kindheit bis zu den ersten pubertären Anzeichen ist eine hormonell eher ruhige Zeit. Nur ganz wenige Kinder entwickeln diesbezügliche Krankheitsbilder. Eine Zystitis ist die echte Rarität, und wenn dann sollte dem umso genauer nachgegangen werden.
Wie verhält es sich dann im jungen Erwachsenenalter?
Wenn die Geschlechtsreife eingesetzt und der Zyklus sich eingependelt hat, wenn Verhütungsmethoden angewendet werden und es zu Geschlechtsverkehr kommt, dann kommen natürlich auch öfter Keime ins Spiel und die Häufigkeit der Infek-
tionen steigt. Promiskuität ist in jedem Lebensalter ein Risikofaktor. Uns ist der antiquierte Begriff Honeymoon-Zystitis bekannt: Durch viel Verkehr auf der Hochzeitsreise und die damit einhergehende mechanische Irritation kann es ebenfalls zur Zystitis kommen. Viele junge Frauen verlagern halt die HoneymoonZystitis heute in jüngere Jahre, ohne Honeymoon (lacht). Aber selbstverständlich kann auch in diesem Alter eine Infektion ohne Verkehr auftreten. Als Ärzte sollten wir das anders interpretieren, als wenn wirklich Keime im Spiel sind, wenn handfeste Erregernachweise vorliegen.
Und wie sieht es in den weiteren Lebensphasen aus?
Auch Schwangere neigen zu vermehrten Harnwegsinfekten mit oder ohne Verkehr. Die Schwangerschaft ist hormonell noch ein größerer Supergau für die Frau als die Pubertät. Verständlicherweise.
In der Menopause haben wir das ganze unerfreuliche Spiel erneut: Die Umstellung der Hormone bedingt eine Umstellung des pH-Werts und eine Anfälligkeit für Infektionen. Mit oder ohne Verkehr, beides ist möglich. In dieser Lebensphase kommt oft die trockene Scheide hinzu. Sie prädestiniert für Infektionen.
Im höheren Alter können z. B. verordnete Medikamente, insbesondere harntreibende Mittel, oder eine Inkontinenz mitspielen. Auch Immobilität ist ein Thema. Keime spielen nicht mehr eine so große Rolle, da oft kein oder nur selten Verkehr stattfindet. Natürlich können durch Toilettenfehler oder anale Inkontinenz Keime von anal in die Vagina oder Urethra wandern.
Welche Bedeutung kommt der frühzeitigen Therapie zu?
Sowohl präventive Mittel als auch Therapieformen bei bereits vorliegender Problematik sind wichtig. Frauen setzen generell ein hohes Vertrauen in pflanzliche Produkte. So auch beim Harnwegsinfekt. Seit Jahren werden Pflanzenextrakte zur Prävention und Therapie in dieser Indikation erfolgreich eingesetzt. Nicht jedes Präparat wird von jedem vertragen, und
es gibt auch in der Phytotherapie Gewöhnungseffekte. Deshalb ist es hilfreich, wenn neue Präparate auf den Markt kommen, auf die man umsteigen kann – darunter auch intelligente Kombinationen von Pflanzenextrakten, die sich ergänzen.
Können Sie uns ein Beispiel nennen?
In Österreich ist seit geraumer Zeit eine Dreierkombination bestehend aus Hauhechelwurzel, Orthosiphonblätter und Goldrute als Arzneimittel zugelassen. Wirksamkeit und Unbedenklichkeit sind klinisch belegt. Es bekämpft nicht nur ein breites Erregerspektrum und lindert die Symptome, sondert fördert bei gleichzeitig reichlicher Flüssigkeitszufuhr auch die Durchspülung der ableitenden Harnwege, Blase und Harnröhre. Die Anwendung ist in jeder Lebensphase möglich, auch bereits bei Teenagern ab 12 Jahren während der akuten Symptomatik. Nach Abklingen der Beschwerden sollte es noch einige Tage weiterverwendet werden.
Wenn aufgrund des Erregernachweises und der schweren Symptomatik Antibiotika notwendig sind: Was bringt eine begleitende pflanzliche Therapie?
Frauen haben oft instinktiv das Gefühl, dass sie, bildlich gesprochen, nicht nur die Keime mit dem Antibiotikum bekämpfen wollen. Sie wollen sich auch heilen und pflegen und den Nieren und den ableitenden Harnwegen Gutes tun. Mit pflanzlichen Präparaten ist das gewährleistet.
Ihr Fazit?
Harnwegsinfekte sind in der Praxis häufig. Man sollte dabei nicht immer nur an eingeführte Keime denken. Oft ist es auch ein endogenes Problem. Meist ist es – vor allem bei der Frau – ein individuelles, kein Paarproblem. Mädchen und Frauen wissen oft recht genau, was bei ihnen die Entstehung einer Zystitis beschleunigt. Das lässt sich für die Prävention nutzen. Ab den Wechseljahren ist es wichtig, die trockene Scheide mitzubehandeln. Damit bekommt man meist auch den Harnwegsinfekt gut in den Griff.
Das Interview führte Mag.a Karin Martin.
30 Juni 2023 Hausärzt:in DIALOG Gyn/Uro
© Ernst Kainerstorfer

Fachkurzinformation siehe Seite 50
Brustkrebserkennung –neue Technologien in der Diagnose


Die Mammografie liefert nicht bei allen Frauen gleich gute Ergebnisse
Bei Brustkrebs, der häufigsten Krebserkrankung der Frau, kommt der Früherkennung eine besondere Bedeutung zu.1 In Österreich wird sie im Rahmen des BKFP (Brustkrebs-Früherkennungsprogramm) seit 2014 angeboten. 2 Die Mammografie ist ein seit Jahrzehnten bewährtes Verfahren, um kleinste Veränderungen in der Brust aufzuspüren –vorausgesetzt, die technische Qualität der Geräte und die medizinische Qualität der Befundung entsprechen den aktuellen Standards. Die Einführung der digitalen Mammografie, insbesondere die Verwendung von Flach-

detektoren, stellt einen wesentlichen technologischen Fortschritt dar. Es ist aber bekannt, dass die Mammografie nicht bei allen Frauen gleich gute Ergebnisse liefert. Beispielsweise sinkt bei dichtem Drüsengewebe die Sensitivität dieses Verfahrens – bei extrem dichtem Brustgewebe (ACR D) sogar auf unter 50 %. 2 Manche Tumoren lassen sich durch ihre dem umliegenden Brustgewebe ähnlichen Dichte im Mammogramm schwer darstellen. Eine zusätzliche Ultraschalluntersuchung, zumindest bei den ACR-Dichten C und D – wie sie auch im österreichischen
GASTAUTOR:INNEN-TEAM:
32 Juni 2023 Hausärzt:in DIALOG Gyn/Uro
DDr. Friedrich Semturs, MAS Medizinphysikexperte, MedUni Wien, Zentrum für Medizinische Physik und Biomedizinische Technik
Elfriede Sturm Radiologietechnologin, Univ.-Klinik für Radiologie und Nuklearmedizin, Universitätsklinikum AKH Wien © shutterstock.com/Khorzhevska
© privat © privat
BKFP durchgeführt wird –, verbessert die Sensitivität deutlich.1 Die neuen Technologien adressieren diese Problematik und erhöhen daher vor allem die Befundungsqualität bei dichterem Brustgewebe.
Digitale Brusttomosynthese (DBT)
Diese seit über einem Jahrzehnt verfügbare Schichtaufnahmetechnik ermöglicht die Ausblendung von Überlagerungen innerhalb des Brustgewebes und verbessert dadurch die Erkennung und Beurteilung von Läsionen. Die Röntgenröhre bewegt sich dabei über der komprimierten Brust und fertigt mehrere (herstellerabhängig bis zu 25) LowDose-Aufnahmen an, aus denen danach Schichtaufnahmen parallel zur Detektoroberfläche rekonstruiert werden. Es ist anschließend möglich, die Brust schichtweise zu betrachten, um Auffälligkeiten besser zu erkennen. Parallel dazu wird vom Mammografiesystem auch ein sogenanntes synthetisches 2DBild angefertigt, das einer herkömmlichen Mammografieaufnahme gleicht und daher eine gute Übersichtsdarstellung der Brust bietet. Immer mehr Hersteller nutzen Algorithmen der Künstlichen Intelligenz, um Auffälligkeiten aus den Tomoschichten herauszufiltern und diese gezielt ins synthetische Bild zu übertragen.
In den letzten Jahren ist eine Vielzahl von Studien zum Thema Tomosynthese veröffentlicht worden – so gut wie alle diagnostizieren einen Vorteil in Sensitivität und Spezifität gegenüber dem „normalen“ Mammogramm, insbesondere eine höhere Detektionsrate von invasiven Karzinomen. In vielen Radiologieinstituten und Kliniken gehört die Anwendung der Tomosynthese inzwischen zum Alltag. 3,4 In Österreich haben mehr als 50 % der Mammografieinstitute diese Schichtaufnahmetechnik im Routineeinsatz.
Dedicated Breast CT (DBCT)
Um eine „echte“ 3D-Bildgebung zu erhalten, benötigt man ein speziell für die Brustbildgebung konstruiertes CTGerät, auf dem die Patientin in Bauch-
lage gelagert wird. Jeweils eine Brust ragt durch die Öffnung im Lagerungstisch, muss aber nicht komprimiert werden – was von den Frauen als sehr angenehm empfunden wird. Seit ein paar Jahren steht ein derartiges Gerät, das mit Photonenzählertechnologie arbeitet, als marktreifes Produkt zur Verfügung. Die Brust wird hierbei für ein paar Sekunden spiralförmig abgetastet und daraus wird ein dreidimensionales Volumen rekonstruiert. Erste Ergebnisse zeigen, dass auch bei dieser Technologie eine Kontrastmittelgabe empfohlen wird, wenn eine hohe Brustdichte vorliegt. 5 Die Strahlendosis entspricht mittlerweile jener einer Mammografie in zwei Ebenen. Es gibt schon mehrere Installationen in der Schweiz und in Deutschland, jedoch derzeit noch keine in Österreich.
Kontrastmittelverstärkte Mammografie (CEM)
Ein noch nicht so verbreitetes spezielles Mammografieverfahren stellt die CEM („C ontrast Enhanced Mammography“) dar.
Seit 2010 ist es möglich, die digitale Mammografie mit einer intravenösen Kontrastmittelanwendung zu kombinieren, um eine funktionelle Aussage –ähnlich wie bei der MRT – zu erzielen.6 Man benötigt dazu ein erweitertes Mammografiegerät (Hard- und Software) sowie ein jodhaltiges Röntgenkontrastmittel in üblicher Konzentration, welches sich schon nach ca. zwei Minuten in der potentiellen Läsion anreichert. Die Aufnahmen werden im „ Dual Energ y“-Modus durchgeführt, d. h., zwei Aufnahmen mit unterschiedlichen Energien werden knapp hintereinander angefertigt und anschließend voneinander subtrahiert. Für die Patientin bedeutet das eine nur unmerklich verlängerte Kompressionszeit. Bei der Befundung sieht man einerseits eine „normale“ Aufnahme, auf der man z. B. potentiellen Mikrokalk gut beurteilen kann. Andererseits erhält man ein Bild mit Aussage zum Kontrastmittelanfärbeverhalten im Tumor. Es gelten die üblichen Maßnahmen zur Patientinnensicherheit bei der Anwendung von Röntgenkontrastmitteln
(normale Nieren- und Schilddrüsenfunktion, keine bekannte Überempfindlichkeit etc.).
Diese Methode stellt in vielen Fällen eine gute Alternative zur Magnetresonanztherapie mit ähnlicher Aussagekraft dar, insbesondere auch bei Patientinnen mit MRT-Kontraindikationen.7 Derzeit wird diese Technologie vor allem im Assessment angewandt, zum Beispiel bei einem unklaren Screeningbefund.
Artificial Intelligence (AI) –Deep Learning
In letzter Zeit wird – insbesondere bei der Befundung – vermehrt Software eingesetzt, die auf Algorithmen von selbstlernenden künstlichen neurologischen Netzwerken basiert. In einer Reihe von Studien werden zurzeit unterschiedliche Gebiete der Medizin in Bezug auf die Anwendbarkeit von Deep Learning evaluiert. Im Idealfall wird so ein System mit Daten trainiert (z. B. Mammografiebilder mit zugeordneten korrekten Befunden). Danach können zukünftige Bilder über diese Algorithmen analysiert und eine Tumorwahrscheinlichkeit vom System als Befundvorschlag an die Radiologinnen und Radiologen weitergegeben werden.8
Da durch neue radiologische Verfahren eine immer größer werdende Datenmenge anfällt, kann durch diese Unterstützung im Befundungsprozess einiges an Zeit eingespart sowie die Diagnosesicherheit erhöht werden. Hierdurch stehen mehr Ressourcen für den persönlichen Kontakt mit den Patientinnen zur Verfügung. In Österreich ist gegenwärtig der Routineeinsatz solcher Systeme im BKFP noch nicht vorgesehen.
Literatur:
1 Das österreichische Brustkrebs-Früherkennungsprogramm BKFP, frueh-erkennen.at
2 Sardanelli F et al., Insights Imaging. 2017 Feb; 8(1):11-18. doi: 10.1007/s13244-016-0531-4.
3 Semturs F et al., Radiologe. 2010 Nov;50(11): 982-90. doi: 10.1007/s00117-010-2012-y.
4 Smith AP, Design Considerations in Optimizing a Breast Tomosynthesis System. White paper, 2011. 5 Schmidt CS et al., Clin Imaging. 2022 Oct;90:50-58. doi: 10.1016/j.clinimag.2022.07.001.
6 Dromain C et al., Breast Cancer Res. 2012 Jun 14; 14(3):R94. doi: 10.1186/bcr3210.
7 Pötsch N et al., Radiology. 2022 Oct;305(1): 94-103. doi: 10.1148/radiol.212530.
8 Leibig C et al., The Lancet Volume 4, Issue 7, July 2022. doi: 10.1016/S2589-7500(22)00070-X
Juni 2023 33 Hausärzt:in DIALOG Gyn/Uro
<
Postvirale Zustände
Welche Patient:innen brauchen Rehabilitation nach COVID-19?
Nach drei Jahren Pandemie der akuten COVID-19-Erkrankung müssen wir feststellen, dass es eine zweite Pandemie gibt: jene der Patientinnen und Patienten mit überstandener COVID19-Erkrankung. Viele der Betroffenen hatten keinen schweren oder gar kritischen Verlauf. Die interdisziplinäre Abklärung ist komplex, eine Therapieoption bietet die Rehabilitation. Zusammen mit Expertinnen und Experten aus vielen Fachgesellschaften hat die Österreichische Gesellschaft für Allgemeinmedizin (ÖGAM) eine S1Leitlinie zur Diagnostik und Therapie von Menschen mit Long COVID publiziert.
Definition und Phänotypisierung
Das Robert Koch-Institut hat bereits im Mai 2020 eine Einteilung der Schweregrade der akuten Erkrankung wie folgt empfohlen:
• milder Verlauf: Husten und Fieber (Influenza-like-Illness)
• moderater Verlauf: Pneumonie (ohne Hospitalisierung)
• schwerer Verlauf: hospitalisierte Fälle
• kritischer Verlauf: Intensivstation Dass fast alle mit schwerem oder kritischem Verlauf im Anschluss eine Rehabilitation benötigen, scheint schlüssig, und der Bedarf ist dank der hervorragenden Infrastruktur in Österreich mit der Möglichkeit der stationären und/ oder ambulanten Rehabilitation gut gedeckt. Dass es aber eine nicht unbeträchtliche Zahl von Personen gibt, die nach einem milden oder moderaten Verlauf über lange Zeit Beschwerden haben, ist nicht selbstverständlich.
Die Definition des Post-COVID-Syndroms bzw. von Long/Post COVID ist eine rein zeitliche, keine klinisch symptomorientierte. Mit dem Versuch, das zu definieren, ist mehr Unklarheit entstanden als klinisch Relevantes. Wir sollten also daran arbeiten, die Patienten zu phänotypisieren und in Gruppen einzuteilen, die unterschiedlich zu bewerten sind. Bei all diesen Phänotypen


handelt es sich um postvirale Zustände, weshalb die WHO auch den ICD-Code U09 mit „ Post COVID-19 condition“ definiert, was in der deutschen Übersetzung mit „ Zustand“ etwas holprig klingt.
Klinisch relevante Verbesserung
In Österreich haben wir ein flächendeckendes Angebot stationärer Rehabilitation mit viel Erfahrung und hohem Spezialisierungsgrad. Zusätzlich gibt es in den Ballungszentren das Angebot der ambulanten Reha – von Bregenz bis Eisenstadt. Erste Publikationen zum Thema Rehabilitation bei Long COVID konnten die Machbarkeit, Sicherheit und Effektivität nach einem schweren Verlauf zeigen. Nach einer dreiwöchigen stationären Rehabilitation verbesserten sich sowohl die körperliche Leistungsfähigkeit klinisch rele-
Hausärzt:in medizinisch 34 Juni 2023
© shutterstock.com/Panchenko Vladimir
GASTAUTOR: Prim. Dr. Ralf Harun Zwick Ärztlicher Leiter, Ambulante Internistische Rehabilitation, Therme Wien Med
vant (6-Minuten-Gehtest: mittelschwer Betroffene: +48 m, schwer Betroffene: +124 m) als auch die psychosomatischen Parameter Angst, Traumatisierung und Depression. Dieselben Erfahrungen haben wir in sechswöchiger ambulanter Rehabilitation gemacht. Es kam zu einer klinisch relevanten Verbesserung des 6-Minuten-Gehtests um +62,9 m mit einer „number needed to treat“ (NNT) von 1,4. Die Mehrzahl der Patientinnen und Patienten verbesserte sich um mehr als den „m inimal clinical important differenc e“ (MCID) von 30,5. Nur sehr wenige hatten keinen Benefit in Form einer Reduktion der Fatigue (NNT 1,9) und einer Verbesserung der Dyspnoe (NNT 1,8) – publication accepted 1/22. Weitere Studien zeigten eine Verbesserung der restriktiven Lungenfunktionsveränderungen, der Diffusionsstörung und der Atemmuskelkraft auf.
Rolle des vegetativen Nervensystems
Wir haben in den letzten Monaten viele Patientinnen und Patienten mit Long COVID gesehen und behandelt. In der Publikation haben wir sie je nach Schweregrad des initialen Verlaufs in hospitalisierte und nicht hospitalisierte eingeteilt. Das Erstaunliche ist, dass auch viele Personen mit vermeintlich „m ilden“ Verläufen nach 4,4 Monaten dieselben Beschwerden haben wie diejenigen, die hospitalisiert oder gar auf der Intensivstation waren.

IM ÜBERBLICK
Tipps für die Praxis:
Wenn Sie erstmals eine Patient:in mit den Folgen einer SARS-CoV-2-Infektion sehen, dann sollten Sie auf der Basis des Leitsymptoms die Routineabklärung durchführen.
Sie können nach Ausschluss der „red flags“ getrost eine Kontrolle in wenigen Wochen vereinbaren, weil davon auszugehen ist, dass sich die postviralen Beschwerden bei den meisten von selbst bessern.
Falls die Routinediagnostik kein Korrelat ergibt, führen Sie einen Schellong-Test durch, der auf eine autonome Dysfunktion hinweisen kann.
Patient:innen, die bei dieser Kontrolle noch überproportional im Alltag/in der Arbeit eingeschränkt sind, sollten einer Rehabilitation zugewiesen werden.

Zwei häufig von Patient:innen gestellte Fragen:
V „Werden diese Beschwerden aufhören?“
☛ Man kann davon ausgehen, dass die Beschwerden in den nächsten fünf Wochen verschwinden.
V „Wann kann ich wieder Sport treiben?“
☛ Empfehlenswert ist es, eine Woche völlig beschwerdefrei zu sein. Dann kann man sich wieder an die alte Leistungsfähigkeit herantasten.
ICH EMPFEHLE MYSUGR UM DEN ÜBERBLICK ZU BEHALTEN!
Meine Patienten können:
1. Accu-Chek Blutzuckermessgerät* mit der mySugr App** verbinden.

2. Messwerte automatisch übertragen und zusätzliche Informationen hinzufügen.
3. Analysen & Reports ansehen, und z.B. als PDF per E-Mail teilen oder ausgedruckt mitnehmen.
* Accu-Chek Mobile benötigt einen Adapter [kostenlos erhältlich auf www.accu-chek.at].


** mySugr Pro ist in Verbindung mit einem Accu-Chek Blutzuckermessgeräte KOSTENLOS [statt € 27,99 jährlich].

SCHLUSS MIT HANDGESCHRIEBENEN TAGEBÜCHERN. ACCU-CHEK, ACCU-CHEK GUIDE, ACCU-CHEK INSTANT, ACCU-CHEK MOBILE und MYSUGR sind Marken von Roche. Alle weiteren Produktnamen und Marken gehören den entsprechenden Eigentümern. © 2023 Roche Diabetes Care | www.accu-chek.at | Roche Diabetes Care Austria GmbH | 1210 Wien | Engelhorngasse 3
Simone hat Typ-2 Diabetes. Sie ist mySugr Fan.
>
In unserem Kollektiv hatten unabhängig vom Schweregrad der Infektion fast 70 % Dyspnoe, 63 % Fatigue und fast 40 % neurokognitive Defizite. Jene Beschwerden sind häufig auf eine autonome Dysfunktion zurückzuführen. Sie lässt sich einfach mit einem Schellong-Test diagnostizieren, der beim Wechsel vom Liegen zum Aufstehen eine überschießende hypersympatikotone Dysfunktion mit überproportionalem Anstieg der Herzfrequenz, des diastolischen und systolischen Blutdrucks zeigt. Wir schicken diese Patientinnen und Patienten dann weiter zur neurologischen Abklärung inklusive einer Kipptischuntersuchung. Als Therapie konnten in prospektiv randomisierten Studien einfache Maßnahmen wie Kompressionsstrumpfhosen Klasse II, 10 g NaCl/Tag und 3-4 l Flüssigkeit/Tag Erfolge bewirken. Eine rezente Publikation fasst die Symptome, Tests und Therapiemöglichkeiten sehr gut zusammen. Die Domäne der Rehabilitation beinhaltet hier die erstmalige Diagnostik der autonomen Dysfunktion, die Therapie mit Pacing und Training sowie die beschriebenen nichtmedikamentösen Interventionen. Nach fach-
ärztlicher Begutachtung durch die Neurologie kann diese um medikamentöse Therapien erweitert werden. Weiters gibt es verschiedenste neue Konzepte, die spezialisierten Zentren überlassen bleiben – sie reichen von der Behandlung der endothelialen Dysfunktion, der Durchblutungsstörungen/Thrombozytenaktivierung und der Mastzellaktivierung bis hin zu Immunglobulinen oder Plasmapherese.
Evaluation der Alltagsfunktion
Die Gruppe der Personen mit „m ilden Verläufen“ war in unserem Kollektiv durchwegs jünger – im Schnitt 43 Jahre alt – und zu 60 % weiblich. Das bestätigt die Autoimmunhypothese, da bei Frauen auch Autoimmunerkrankungen gehäuft vorkommen. Das Kollektiv der „schweren Verläufe“ war im Schnitt 10 Jahre älter und zu 85 % männlich. Dies deckt sich mit anderen Erfahrungen im klinischen Alltag, nach denen Kolleginnen und Kollegen berichten, sie könnten Personen mit Long COVID klinisch so schwer einschätzen.
Die funktionelle Einschränkung lässt sich messen (siehe Abbildung). Ab Grad 2 ist laut Leitlinien eine Rehabi-
Können Sie allein leben, ohne Unterstützung durch eine andere Person? (z. B. selbstständig essen, gehen, die Toilette benützen und die tägliche Routinehygiene bewältigen)
litation indiziert. Hier kam es zu einer deutlichen Verbesserung der „ Post COVID-19 Functional Status Scale“ –die NNT betrug 1,2 bei der Mehrzahl der Patientinnen und Patienten.
Fazit
Zusammenfassend bietet die Rehabilitation die Möglichkeit einer effektiven Therapie von schweren oder kritischen Verläufen, zusätzlich konnten wir aber vielen Menschen mit milden oder moderaten Verläufen diagnostisch helfen. Rehabilitation führt zu einer Verbesserung von Leistungsparametern und zu einer funktionellen Verbesserung der Patientinnen und Patienten mit Post/ Long COVID.
S1-Leitlinie Long COVID und weiterführende Informationen – das Webtool: kl.ac.at/allgemeinegesundheitsstudien/long-covid-leitlinie

Gibt es Aufgaben/Aktivitäten zu Hause oder am Arbeitsplatz, die Sie nicht mehr selbst ausführen können?
Leiden Sie unter Symptomen, Schmerzen, Depression oder Angstzuständen?
Müssen Sie Aufgaben/Aktivitäten vermeiden, reduzieren oder über die Zeit verteilen?
Post-COVID-19-Skala des funktionellen Status – Flussdiagramm für den Selbstbericht von erwachsenen Patient:innen. Quelle: modifiziert nach Klok FA et al., Eur Respir J. 2020; 56: 2001494.
Hausärzt:in medizinisch 36 Juni 2023
Ja Nein Ja Nein Nein Ja Ja
keine funktionelle
Grad 0
Einschränkung
Grad 1 vernachlässigbare funktionelle Einschränkung
Grad 2 leichte funktionelle Einschränkung
mäßige funktionelle
Grad 3
Einschränkung
Nein
Grad 4 schwere funktionelle Einschränkung
<
Weitere Literatur beim Verfasser.
Erfreuliche Ergebnisse
Fast ein Drittel mehr innovative Arzneimittel im Jahr 2022
NACHGEFRAGT:
Arzneimittelinnovationen, quo vaditis?
„In klinischer Forschung ist Innovation zentral“

Assoc. Prof. Priv.-Doz. Dr. Markus Zeitlinger, Abteilung für Klinische Pharmakologie, MedUni Wien
„In den letzten Jahren haben innovative Studiendesigns und Pathways in der klinischen Forschung Einzug gehalten. Über verschiedene Indikationen hinweg ist ein Trend von der symptomgetriebenen Zulassung zur ursachenbasierten Indikation zu erkennen. Vor allem bei Seltenen Erkrankungen ermöglicht das die Durchführung von kontrollierten Studien. Anstelle von Mammakarzinom oder Ovarialkarzinom spricht man also von Krebszellen mit bestimmten Mutationen wie BRCA, anstelle von Pneumonie und Zystitis von Infektionen, die durch bestimmte hochresistente Keime verursacht werden. Ist auch das nicht mehr möglich, können sogenannte adaptive Studiendesigns dazu beitragen, die Arzneistoffentwicklung zu straffen oder im Falle von sehr seltenen Erkrankungen überhaupt zu ermöglichen.
Insgesamt 54 Medikamente mit neuem Wirkstoff konnten im vergangenen Jahr in Österreich zugelassen werden.
„Ü ber die letzten zehn Jahre betrachtet, kamen über 400 innovative Pharmazeutika auf den Markt und eröffneten Ärzt:innen und Patient:innen neue Behandlungsoptionen“, hob Dr. Michael Kreppel-Friedbichler, Vizepräsident des Forums der forschenden pharmazeutischen Industrie in Österreich (FOPI), bei einem Pressegespräch in Wien* hervor. DI Dr. Günter Waxenecker, Geschäftsfeldleiter der AGES-Medizinmarktaufsicht, nannte sechs herausragende Beispiele:
Denguevirus-Impfstoff: Dabei handelt es sich zwar schon um eine zweite Denguefieber-Vakzine, aber es ist die erste, die auch für seronegative Personen (wie in der EU üblich) verwendet werden kann. Der attenuierte Lebendimpfstoff ist gegen vier Serotypen von Dengue wirksam.
Lenacapavir: Der allererste Wirkstoff aus der neuen Klasse der CapsidInhibitoren wirkt auch gegen multiresistente HIV-1-Infektionen. Die HIV-
First-in-Class-Therapie erfordert nur zweimal jährlich eine Verabreichung als subkutane Injektion.
Lutetium (177Lu) vipivotidetetraxetan: Hierbei handelt es sich um eine neue, zielgerichtete Radioligandentherapie für das metastasierte therapierefraktäre Prostatakarzinom.
Relatlimab: Der monoklonale Antikörper stellt eine weitere Option in fixer Kombination für Patient:innen mit Melanom dar, die wenig PD-L1 exprimieren.
Tirzepatid: Dieser erste duale GIP- und GLP-1-Rezeptoragonist ist bei unzureichend eingestelltem Diabetes mellitus Typ 2 wirksam und muss nur einmal pro Woche als subkutane Injektion verabreicht werden.
Valoctocogeneroxaparvovec: Das Gentherapeutikum mit dem adenoassoziierten Virus des Serotyps 5 (AAV5) als Vektor ermöglicht eine erste Gentherapie bei schwerer Hämophilie A in der EU.
Und schlussendlich helfen uns computerbasierte Simulationen dabei, hypothetische Patient:innen zu generieren, etwa um die optimale Dosierung von Arzneistoffen zu ermöglichen oder die Erfolgsrate eines Medikaments für eine heterogene Population abzuschätzen.“
Mag. a Andrea Brunner, Geschäftsführerin der Aids Hilfe Wien
„Die Entwicklung neuartiger Ansätze hat das Leben von Menschen mit HIV in den letzten Jahrzehnten positiv beeinflusst. Während eine HIV-Infektion in den 1980er-Jahren dramatische Auswirkungen hatte, können Betroffene heute unter wirksamen Therapien ein normales Leben mit guter Lebensqualität führen. Und sie können das Virus bei konsequenter Anwendung der Therapie nicht weitergeben. Das ist bekannt. Aber auch heute noch bringen moderne Arzneimittel weitere Verbesserungen mit sich. Darum ist jeder neue Therapieansatz, der für die konkrete Lebenssituation von Menschen mit HIV eine Erleichterung bringt, sehr zu begrüßen. Patient:innen haben so die Wahl zwischen mehreren Optionen. Wichtig ist mir, dass die Therapien auch in ärmeren Ländern der Welt zur Verfügung gestellt werden.“
Hausärzt:in pharmazeutisch 37 Juni 2023
© FOPIForum der forschenden pharmazeutischen Industrie/ APA-Fotoservice/Hörmandinger
Mag.a Karin Martin * Pressegespräch „Arzneimittel-Innovationen“ von AGES und FOPI, 9. Mai 2023, Wien.
Am Podium (v.l.n.r.): Mag.a Andrea Brunner/Aids Hilfe Wien, Dr. Michael Kreppel-Friedbichler/FOPI, DI Dr. Günter Waxenecker/AGES, Prof. Dr. Markus Zeitlinger/MedUni Wien.
„Innovative Therapien haben eine lebensverändernde Wirkung“
Wirkmechanismen, Wirtsbäume und Selbstregulation
In der modernen Onkologie wird die Misteltherapie gerne komplementär zu Chemotherapeutika, monoklonalen Antikörpern oder Östrogenrezeptorblockern eingesetzt. Dabei kommt den Wirtsbäumen der Misteln eine besondere Bedeutung zu: Grund dafür ist, dass sich die Inhaltsstoffe nicht nur im Jahresverlauf ändern, sondern auch –je nachdem, auf welchem Baum die Pflanze wächst – unterschiedlich sind. Bei einem aktuellen Live-Webinar des FFN® – Fortbildungsforum Naturheilkunde wusste Sarah Monz, Fachärztin für Anästhesiologie und Spezielle Schmerztherapie sowie Geschäftsleitungsmitglied der Iscador AG, viel über die Heilpflanze und ihre Wirkungsweise zu erzählen. „Die Mistel ergänzt die Schulmedizin im Sinne eines ganzheitlichen Ansatzes“, hob sie hervor. „Zahlreiche wissenschaftliche Studien bestätigen die klinische Wirksamkeit der komplementärmedizinischen Anwendung.“
So lassen sich heute z. B. die Leitsubstanzen der Mistel messen: die Lektine und die Viscotoxine. „ Diese machen im Extrakt im richtigen Verhältnis, nämlich Sommer zu Winter (1 : 1) die Wirksamkeit einer Misteltherapie aus“, erklärte Monz. „ Beim Herstellungsprozess werden die Säfte fermentiert und dann im richtigen Verhältnis zueinander vermischt.“
Inhaltsstoffe der Mistel
Misteln enthalten etliche anerkannte Wirkstoffe. Dazu zählen – neben den Lektinen und den Viscotoxinen – Flavonoide, Phenylpropane, Polysaccharide und Triterpene. Deren Beitrag für die Wirksamkeit wird zwar als gering angesehen, sie können jedoch mit den Lektinen und Viscotoxinen interagieren. Die Mistellektine sind vor allem im Winter im inneren Bereich der Pflanze vorhanden und schützen sie vor Fraß. Die Viscotoxine sind im Sommer an den Blättern vorhanden und bewahren sie vor Insektenbefall. „Gibt man die Lektine im Labor zu Tumorzellen, dringen sie ins Zellinnere ein und inaktivieren die Ribosomen – also jenen Ort, wo Eiweißzellen hergestellt werden – und führen eine Apoptose, also einen programmierten Zelltod, herbei“, schilderte Monz die Hintergründe. „ D ie Viscotoxine wiederum machen von außen Poren in die Tumorzelle, was durch eine Zellwandschädigung ebenfalls dazu beiträgt, dass sie abstirbt.“ Zu beachten sei bei der Wahl der passenden Mistel, dass die einzelnen Wirtsbäume unterschiedliche Konzentrationen der Leitsubstanzen aufwiesen. Wobei: In der richtigen Zusammensetzung könne auch wenig davon eine optimale Wirkung erzielen.
Den richtigen Wirtsbaum finden

Kiefer, Apfelbaum, Eiche – die Mistel gedeiht auf den unterschiedlichsten Bäumen. Mittels Signaturenlehre wird bestimmt, welche Art bei den verschiedenen Krankheiten zum Einsatz kommt. Diese Lehre geht von der Annahme aus, dass die Natur Hinweise gibt, welche Pflanze als Heilpflanze verwendet werden kann. „ M isteln auf Laubbäumen besitzen mehr Lektine und werden eher für Tumorgeschehen im Inneren des Körpers genütz t“, so Monz. „ Jene von Nadelbäumen wiederum enthalten mehr Viscotoxine und bieten sich für Prozesse auf der Haut an.“ Auch die Gendermedizin stelle
Evidenzbasierte Empfehlung
Die „S3-Leitlinie Komplementärmedizin in der Behandlung von onkologischen PatientInnen“ bestätigt mit 1a-Evidenzgrad, dass Mistelgesamtextrakt als Therapeutikum zur Verbesserung der Lebensqualität subkutan gegeben werden kann.
Quelle: leitlinienprogramm-onkologie.de/ leitlinien/komplementaermedizin
Hausärzt:in pharmazeutisch 38 Juni 2023
Die Mistel gilt als eine der ältesten Heilpflanzen – mit großem Erfolg wird sie heute in der Onkologie angewendet
© shutterstock.com/Ja Crispy
INFO
einen wichtigen Aspekt dar. So werde etwa die Eiche mit männlichen Archetypen assoziiert und der Apfelbaum mit weiblichen. Allerdings gebe es, was die Konstitution eines Menschen betreffe, weiblich wirkende Männer und virile Frauen. Monz: „ Betrachtet man die Konstitution eines Menschen, so kann also durchaus die Eichenmistel auch zu einer Frau passen und umgekehrt. Wichtig: Grundsätzlich gibt es niemals den falschen Wirtsbaum. Man kann mit seiner Wahl die Behandlung nur optimieren.“
Selbstregulation unterstützen
Insbesondere Menschen mit einer onkologischen Erkrankung fallen nach ihrer Diagnose oft in ein tiefes Loch und sind nicht mehr zur Selbstregulation fähig. Das bedeutet, sie können nur schwer ihre Gefühle und Gedan-
ken an die Anforderungen der jeweiligen Situation anpassen oder sie verändern. Auch zur Thematik „ A ktiv durch Selbstregulation“ veranstaltete das Fortbildungsforum Naturheilkunde ein Live-Webinar. Dr. Frank Meyer, Facharzt für Allgemeinmedizin und Naturheilverfahren, stellte in seinem Vortrag die Studie „Use of Iscador, an extract of European mistletoe (Viscum album), in cancer treatment“ vor, welche aufzeigt, wie wichtig die Selbstregulation im Rahmen der onkologischen Behandlung ist und dass Patienten mit guter Selbstregulation bei einer gleichzeitigen Misteltherapie die größten Chancen haben, besser und auch länger zu leben (siehe Literatur).
„M ich fasziniert die Tatsache, dass die zwei Faktoren – Selbstregulation und medizinische Behandlung – zusammenwirken“, betonte Dr. Meyer. „ Für mich war das Ergebnis der Studie ein klares
NACHBERICHT

Zeichen dafür, dass man im Gespräch mit onkologischen Patienten diese motivieren sollte, die eigene Aktivität in den Mittelpunkt zu stellen, selbstbestimmt zu handeln und damit zur Stärkung der Selbstregulation beizutragen“, so der Facharzt. „ Die Misteltherapie wirkt seelisch stabilisierend und hilft somit dabei, aus eigenem Antrieb Herausforderungen zu bewältigen, Mut zu fassen, sich auf die Mission bzw. ein Ziel zu fokussieren und – trotz schwerer Erkrankung – ein möglichst selbstbestimmtes Leben zu führen “ Die Lebensqualität verbessere sich nachweislich (siehe Infokasten).
Gabriella Mühlbauer
Literatur:

Grossarth-Maticek R et al., Use of Iscador, an extract of European mistletoe (Viscum album), in cancer treatment: prospective nonrandomized and randomized matched-pair studies nested within a cohort study. Alternative Therapies in Health and Medicine 7.3 (2001): 57.





Live-Webinare Misteltherapie mit ISCADOR „Wirkmechanismus und Wirtsbäume“ und „Aktiv durch Selbstregulation“ des FFN®Fortbildungsforum Naturheilkunde, April 2023.





Integrative Tumorbehandlung mit Misteltherapie






• Signifikante Verbesserung der Lebensqualität 1, 2, 3




• Reduktion krankheits- und therapiebedingter Symptome 1, 2, 3








• Steigerung der körpereigenen Abwehr 4
• Linderung tumorbedingter Schmerzen und der Fatigue 2, 5







Referenzen:




1: Tröger W et al., Breast Cancer Basic and Clinical Research 2009; 3, 35-45
2: Tröger W et al., Dtsch Ärztebl Int 2014; 111: 493-502































3: Loef M et al, BMC Complement Med Ther 2020; 20: 227
4: Schink M et al., Forsch Komplementärmed 2007; 14, 9-17
5: Pelzer F et al., Support Care Cancer 2022
* Level of Evidence 1a
Die «S3-Leitlinie Komplementärmedizin in der Behandlung von onkologischen PatientInnen» bestätigt mit 1a-Evidenzgrad, dass die subkutane Gabe von Mistelextrakt (Viscum album L.) für den therapeutischen Einsatz zur Verbesserung der Lebensqualität bei den Patienten mit soliden Tumoren erwogen werden kann.
leitlinienprogramm-onkologie.de/leitlinien/komplementaermedizin/
Stand der Information: November 2022, ISC_2022_003
Hausärzt:in pharmazeutisch
Wirkung wissenschaftlich bestätigt* Fachkurzinformation siehe Seite 50
SCIENTIFIC UPDATE
Unterstützt von Dr. Böhm®
WISSENSCHAFTLICHE ERKENNTNISSE

ZU PHYTOTHERAPIE UND MIKRONÄHRSTOFFEN
MÜLLER
RESEARCH AND DEVELOPMENT SCIENTIST APOMEDICA
Astaxanthin aus
Haematococcus pluvialis
Ein natürliches Antioxidans für Haut und Gefäße
Astaxanthin aus der Mikroalge Haematococcus pluvialis ist aufgrund seiner chemischen Struktur und Bioverfügbarkeit ein außergewöhnliches Antioxidans. Klinische Studien belegen die Reduktion der LDL-Oxidation im Blutplasma zur Prävention von atherosklerotischer Plaqueformierung. Auf die Haut zeigt Astaxanthin als indirekter biologischer Sonnenschutz photoprotektive Wirkungen. Es ist in der Lage inflammatorische Prozesse zu unterbrechen und die Entstehung von Zellschäden zu verhindern. In Kombination mit anderen Substanzen wie Omega-3-Fettsäuren oder Carotinoiden ergeben sich interessante Wirkkomplexe für den Menschen.

Herkunft
Astaxanthin gilt als stärkstes natürliches Antioxidans und gehört zur Familie der Carotinoide. Durch seine besondere Molekülstruktur zählt es speziell zu den Xanthophyllen, die an einer Fülle von photochemischen Reaktionen in der Natur teilnehmen. Als fettlösliches rotes Pigment ist Astaxanthin für die Rotfärbung von marinen Lebewesen (Lachsen, Krebstieren und Krill) verantwortlich. Es wird von Algen, Hefen (Phaffia rhodozyma) und Mikroorganismen gebildet. Kommerziell wird es jedoch fast ausschließlich aus der Mikroalge Haematococcus
pluvialis gewonnen (Abbildung 1), die mit Abstand die höchsten Konzentrationen an Astaxanthin akkumuliert und in Europa für die Nutzung als Nahrungsergänzungsmittel zugelassen ist.
In photosynthetischen Systemen fungieren Carotinoide als Lichtsammeloder Lichtschutzmoleküle und sorgen für den Schutz in Pflanzen- und Bakterienarten. Auch die grüne Mikroalge Haematococcus pluvialis nutzt die Akkumulierung von Astaxanthin als Überlebensmechanismus, wenn sie Stressbedingungen ausgesetzt ist. Bei erhöhter UV-Strahlung, Nährstoffknappheit oder erhöhter Salinität
wechselt sie in die rote Überlebensphase. So kann sie jahrelange Perioden ohne Nährstoffe und Wasser überdauern (Abbildung 2).1,2
Durch seine Ringstrukturen an den Enden kann das Astaxanthinmole
DIPL. ING. KATHARINA
BEZAHLTE ANZEIGE
Abbildung 1: Mikroskop-Aufnahme der Mikroalge Haematococcuspluvialis
Stoffwechsel- und Vermehrungsphase (grün)
Stressfaktoren: AstaxanthinBildung
kül verschiedene Isomere ausbilden (Abbildung 3). Doch nicht jedes Stereoisomer hat das gleiche antioxidative Potential. Das Astaxanthin-Stereoisomer (3S, 3’S) trägt die antioxidative Kraft der Mikroalge in sich und wird ausschließlich in der Natur gebildet. Es kann nicht synthetisch oder petrochemisch generiert werden und ist die einzige in Europa für den Menschen zugelassene Astaxanthinform.
Astaxanthin aus Mikroalgen kann außerdem sehr gut mit Fettsäuren interagieren und liegt verestert als Mono- und Diester vor. Diese veresterte Astaxanthinformen zeigen eine erhöhte Bioverfügbarkeit und können von Hefen und Bakterien nicht gebildet werden. Hier, wie auch synthetisch, zeigt sich Astaxanthin in freier Form. Darüber hinaus wird die Aktivität von algenbasiertem Astaxanthin noch durch weitere Carotinoide aus der Mikroalge unterstützt und besteht als Carotinoid-Komplex aus kleinen Mengen an Lutein, Canthaxanthin und Beta-Carotin vor. Diese kleinen Unterschiede in der Stereochemie und Beschaffenheit sind dafür verantwortlich, dass Astaxanthin aus Haematococcus pluvialis eine deutlich höhere Bioverfügbarkeit und eine bessere antioxidative Wirkung als die freie Astaxanthin-Form aufweist.2
Oxidativer Stress schädigt
Freie Radikale bilden sich in Verbindung mit Sauerstoff, der für uns Menschen lebensnotwendig ist. Endogen
Abbildung 2: Wachstumsphasen der Mikroalge Haematococcus pluvialis bei optimalen Wachstumsbedingungen und unter Einwirkung von Stressfaktoren.


Überlebensphase (rot)
werden Sauerstoffradikale (ROS) wie Singulett-Sauerstoff (1O2) oder Hydrogenperoxid (H2O2) vorwiegend von den Mitochondrien produziert. Sie fallen jedoch auch bei enzymatischen Reaktionen an, die in die Atmungskette involviert sind. Exogen sind UV-Strahlung, Luftverschmutzung oder andere äußere Stressfaktoren für die Ansammlung von Sauerstoffradikalen im Körper verantwortlich. In niedrigen Dosen übernehmen ROS wichtige Funktionen als Signalmoleküle oder physiologische Biomarker. In zu hohen Dosen können sie oxidativen Stress auslösen, haben negative Effekte auf Membranen, Lipide, Proteine und sind die Ursache für viele Entzündungen im Körper.3

Es gibt körpereigene Systeme, um ROS abzubauen. Diese antioxidativen Abwehrsysteme bestehen aus Enzymen wie Superoxiddismutasen (SOD), Katalasen oder Glutathionperoxidasen und nicht enzymatischen Molekülen wie Liponsäuren, Glutathion, L-Arginin oder Coenzym Q10. Körpereigene Systeme können aber bei weitem die Flut an ROS nicht auffangen.3, 4
Neutralisierende Wirkung von Astaxanthin
Algenbasiertes Astaxanthin verfügt über 13 konjugierte Doppelbindungen. So ist es in der Lage eine große Menge an Elektronen zur Neutralisation von freien Radikalen zu spenden.1 Im direkten Vergleich wirkt Astaxanthin bei der Neutralisierung von SingulettSauerstoff 6000mal stärker als Vitamin C und 100mal stärker als Vitamin E.3 Auch im antioxidativen Wirkbereich unterscheiden sie sich maßgeblich.
Durch seine konjugierten Doppelbindungen, Hydroxyl- und Ketogruppen
Abbildung 3: Chemische Struktur von Astaxanthin
Zell-Äußeres
Radikal
Vitamin C
beta-Carotine Vitamin
Zell-Inneres
Abbildung 4: Transmembranorientierung von Astaxanthin im Vergleich zu Vitamin C, Betacarotin und Vitamin E in der Zellmembran.
E
Astaxanthin
BEZAHLTE ANZEIGE
hat das Astaxanthinmolekül lipophile und hydrophile Strukturen und kann so eine Transmembranorientierung einnehmen (Abbildung 4). Es überträgt an Radikale die fehlenden Elektronen, um sie zu neutralisieren und sicher auszuschleusen. So ist es auf allen Zellebenen antioxidativ wirksam ohne prooxidative Aktivität. Das heißt es wird in höheren Dosen nicht selbst zum Radikal wie z.B. Vitamin E.1
Positive Effekte auf Atherosklerose und die kardiovaskuläre Gesundheit
Die antioxidative Wirkung von Astaxanthin macht es interessant in der Prävention von erhöhtem oxidativem Stress und chronischen Entzündungen, die auch maßgeblich zu kardiovaskulären Erkrankungen und Atherosklerose beitragen. Makrophagen spielen eine zentrale Rolle bei der Entwicklung von Atherosklerose. Die Aufnahme von oxidiertem LDL durch Makrophagen führt zur Bildung von Schaumzellen und zur Genese von gefäßverengenden Plaques (Abbildung 5).
Die Wirkung von Astaxanthin auf die Ursachen von Plaques und Atherosklerose wurde in einigen placebokontrollierten Doppelblindstudien untersucht. In einer Studie mit 24 Probanden hemmte Astaxanthin die LDL-Oxidation signifikant. In einer weiteren Studie mit 44 Probanden erhöhte die Supplementierung von Astaxanthin den Spiegel von High-Density-Lipoprotein (HDL) sowie Adiponektin. Dieses Fettgewebshormon ist gemeinsam mit anderen Hormonen für die Regulierung des Energiestoffwechsels verantwortlich.6,7
Aufgrund der positiven Wirkung von Astaxanthin auf das Lipidprofil und die Lipidoxidation liegt auch eine Kombination mit Omega-3-Fettsäuren aus Algen wie Docosahexaensäure (DHA) und Eicosapentaensäure (EPA) nahe, die blutfettsenkende Eigenschaften mit sich bringen.8 So ergeben sich Synergien für einen ganzheitlichen Schutz der Gefäße.
molekularen Modifikationen und der Produktion von MMP-Enzymen (Metallproteinasen), welche Kollagene und andere elastische Fasern in der Haut zerstören. So wird neben einer voran gegangenen Erythema-Bildung bei oxidativem Stress durch Sonne langfristig die Schädigung der Haut und die Hautalterung vorangetrieben.9
Antioxidantien wie Astaxanthin wirken der Bildung von oxidativem Stress in der Haut entgegen. Eine placebokontrollierte Doppelblindstudie an 22 Probanden hat sich mit der antioxidativen Wirkung von Astaxanthin bei oraler Supplementierung auf UV-induzierte Hautschädigung beschäftigt. Im Vergleich zur Placebogruppe hatte die
Zusätzlich produzieren Makrophagen im Zuge von Entzündungsreaktionen große Mengen an proinflammatorischen Enzymen. Antioxidantien können die überschießende Zytokinsekretion hemmen.5
Photoprotektiver Effekt für die Haut
Die Haut als größtes humanes Organ ist besonders anfällig auf oxidativen Stress, durch äußere Einflüsse wie UVStrahlung und Luftverschmutzung. Oxidativer Stress löst in der Haut Entzündungen aus und führt zu tausenden
+ freie Radikale Aufnahme durch Makrophagen Gefäß
ins
Schaumzelle entsteht
Abbildung 5: Oxidiertes LDL wird leicht von Makrophagen aufgenommen. Astaxanthin hemmt die LDL-Oxidation und damit die Bildung von Schaumzellen bzw. gefäßverengenden Plaques.5
Erhöhte UV-Lichttoleranz Verminderter Feuchtigkeitsverlust 10 9 8 7 6 5 4 3 2 1 0 10 9 8 7 6 5 4 3 2 1 0 Placebo Placebo Astaxanthin Astaxanthin * * BEZAHLTE ANZEIGE
LDL oxid. LDL gehemmt durch Astaxanthin Plaque entsteht
Einlagerung der Schaumzelle
Abbildung 6: Signifikante Zunahme der UVLichttoleranz nach Einnahme von Astaxanthin. Gleichzeitig verliert die Haut weniger an Feuchtigkeit.
Astaxanthingruppe eine erhöhte MED (minimale Erythemdosis) und damit eine höhere Toleranz gegenüber UVLicht. Auch kam es zu einem geringeren transepidermalen Feuchtigkeitsverlust der Haut im Vergleich zu Placebo (Abbildung 6).10
Geeignete Kombinationen
Bei erhöhter UV-Belastung oder Sonnenempfindlichkeit kommen auch andere Antioxidantien zum Einsatz. Natürliches Lycopin aus der Tomate wie auch Lutein aus der Carotinoidfamilie der Xanthophylle oder Zeaxanthin haben sich in placebokontrollierten Doppelblindstudien als Wirkstoffe bei oraler Aufnahme bewährt und steigern die Lichttoleranz der Haut.11 Eines der bekanntesten Carotinoide zum Schutz vor UV-induzierter Erythemabildung ist Betacarotin. Seine antioxidative Wirkung wurde in zahlreichen Studien belegt, jedoch auch die prooxidativen Eigenschaften bei hohen Dosen.12 Diese prooxidativen Reaktionen lassen Carotinoidradikale entstehen, die wieder oxidativen Stress verursachen und zum Beispiel zu Lipidperoxidationen führen.
Natürliches Astaxanthin kann in Kombination mit anderen natürlichen Antioxidantien in einem Antioxidans-Komplex (Abbildung 7) die prooxidativen Eigenschaften von einzelnen Antioxidantien minimieren und reduziert das Risiko von Überdosierungseffekten bei
Langzeiteinnahme von Monopräparaten. In In-vitro-Studien zeigten gerade Carotinoidmischungen aus Betacarotin, Lutein und Lycopin (im richtigen Verhältnis 7:14:79) hohe Schutzwirkung bei lichtinduziertem Stress.13
Eine Studie mit 36 Probanden hat die orale Supplementierung von hochdosiertem Betacarotin (24mg täglich) als Monopräparat im Vergleich zu einem Antioxidans-Komplex (8mg Betacarotin + 8mg Lutein + 8mg Lycopin) über 12 Wochen begleitet. Alle Probanden entsprachen dem Fitzpatrick Hauttyp II, der als „nordischer Typ“ mit heller Hautfarbe beschrieben wird und sehr sensitiv auf erhöhte UV-Belastung reagiert. Beide Supplementierungen zeigten eine reduzierte Erythembildung nach UV-Licht Bestrahlung, Be-
denkt man doch das Risiko der Prooxidation von hochdosiertem Betacarotin und die Gefahr der Initiierung von neuen Radikalkaskaden, wird das Potential von Antioxidans-Komplexen deutlich. Es zeigt sich das Antioxidanskomplexe eine hocheffektive Alternative zu hochdosierten Monopräparaten sind.14
Durch die unterschiedlichen Wirkmechanismen und -ebenen ergeben sich zwischen den einzelnen Antioxidantien Synergien und die Haut kann so ganzheitlich von innen geschützt werden. Die orale Einnahme von Antioxidantien wie Astaxanthin kann keinesfalls die Anwendung von Sonnenschutzprodukten ersetzen, jedoch das Schutzpotential sehr gut ergänzen. UVA- und UVB- Strahlung werden dabei durch topische Sonnenschutzprodukte abgewehrt.15 Eine Ergänzung mit Antioxidantien kann weiteren biologischen Schutz gegen das breite Lichtspektrum der Sonne wie z.B. Blaulicht bieten.
Lycopin Astaxanthin
Zeaxanthin
Lutein
Zusammenfassung
Betacarotin
Antioxidans-Komplex
Abbildung 7: Astaxanthin-Komplex zum ganzheitlichen biologischen Zellschutz der Haut bei erhöhter UV-Belastung zur Unterstützung von topischen Sonnenschutzprodukten.
Natürliches Astaxanthin aus der Mikroalge Haematococcus pluvialis ist mittlerweile ein sehr gut erforschtes Antioxidans, das in der heutigen Zeit als Nahrungsergänzungsmittel bei der Bekämpfung von oxidativem Stress und daraus resultierenden Folgeerkrankungen einen wertvollen Beitrag leisten kann. Gerade in Synergie mit anderen Wirkstoffen zeigt sich das große Potential dieses Naturstoffes.
REFERENCES 1 Ambati RR et al. Astaxanthin: sources, extraction, stability, biological activities and its commercial applications--a review. Mar Drugs 2014; 12 (1): 128–52.; 2 Capelli B et al. Synthetic astaxanthin is significantly inferior to algal-based astaxanthin as an antioxidant and may not be suitable as a human nutraceutical supplement. Nutrafoods 2013; 12 (4): 145–52.; 3 Nishida. Quenching Activities of Common Hydrophilic and Lipophilic Antioxidants against Singlet Oxygen Using Chemiluminescence Detection System. Carotenoid Science 2007; (Vol.11): 16–20.; 4 Pizzino G et al. Oxidative Stress: Harms and Benefits for Human Health. Oxid Med Cell Longev 2017; 2017: 8416763.; 5 Kishimoto Y et al. Potential Anti-Atherosclerotic Properties of Astaxanthin. Mar Drugs 2016; 14 (2).; 6 Mashhadi NS et al. Astaxanthin improves glucose metabolism and reduces blood pressure in patients with type 2 diabetes mellitus. Asia Pac J Clin Nutr 2018; 27 (2): 341–6.; 7 Iwamoto. Inhibition of Low-Density Lipoprotein Oxidation by Astaxanthin. J Atheroscler Thromb 2000; Vol.7, No.4: 216–22.; 8 Innes JK, Calder PC. The Differential Effects of Eicosapentaenoic Acid and Docosahexaenoic Acid on Cardiometabolic Risk Factors: A Systematic Review. Int J Mol Sci 2018; 19 (2).; 9 Donoso A et al. "Therapeutic uses of natural astaxanthin: An evidence-based review focused on human clinical trials". Pharmacol Res 2021; 166: 105479.; 10 Ito N et al. The Protective Role of Astaxanthin for UV-Induced Skin Deterioration in Healthy People-A Randomized, Double-Blind, Placebo-Controlled Trial. Nutrients 2018; 10 (7).; 11 Juturu V et al. Overall skin tone and skin-lightening-improving effects with oral supplementation of lutein and zeaxanthin isomers: a double-blind, placebo-controlled clinical trial. Clin Cosmet Investig Dermatol 2016; 9: 325–32.; 12 Sies H, Stahl W. Nutritional protection against skin damage from sunlight. Annu Rev Nutr 2004; 24: 173–200.; 13 Olaf Eichler. Photoprotektion der Haut durch Carotinoide. Düsseldorf: Heinrich-Heine-Universität, 2000. 112pp. Dissertation.; 14 Heinrich U et al. Supplementation with beta-carotene or a similar amount of mixed carotenoids protects humans from UV-induced erythema. The Journal of Nutrition 2003; 133 (1): 98–101.; 15 Pedić L et al. Recent information on photoaging mechanisms and the preventive role of topical sunscreen products. Acta Dermatovenerologica Alpina Pannonica et Adriatica 2020; 29 (4).;
Weitere Informationen erhalten Sie per E-Mail: science@apomedica.com
SECHS MARKENZEICHEN FÜR QUALITÄT:
BEZAHLTE ANZEIGE
y-doc ist die Nr. 1 im Wartezimmer TV. Das professionelle, nach Ihren Wünschen gestaltete Ordinationsprogramm überzeugt Ihre Patientinnen und Patienten.

y-doc Wartezimmer TV sorgt für eine entspannte Atmosphäre im Wartezimmer, verkürzt die gefühlte Wartezeit und fördert damit ein angenehmes und effizientes Patientengespräch.
+43-732-60 27 28-0
www.y-doc.at
Wartezimmer TV
Zukunftsfittes Gesundheitssystem
Klimakompetenz soll in der Berufsausbildung stärker verankert werden
Die Klimakrise wird von der WHO als die größte Gesundheitsbedrohung unserer Zeit bezeichnet. Der Gesundheitssektor selbst ist zwar ressourcen- und emissionsintensiv, hat dadurch aber auch das Potenzial, einen erheblichen Beitrag für den Klimaschutz zu leisten. Eine Maßnahme stellt hierbei die strategische Implementierung von Klimakompetenzen in die Aus-, Fort- und Weiterbildung aller im Gesundheitssektor Tätigen dar. Dr. Heinz Fuchsig, u. a. Co-Referent des ÖÄK-Referats Umweltmedizin, erklärt in einer Stellungnahme, dass umfassende Fortbildungen angeboten und die bislang überwiegend freiwilligen Vorlesungen der Medizinischen Universitäten verpflichtend werden sollten.

„ Ä rzt:innen sollen und wollen zunehmend wissen, wie sie ihre Wartezimmer hygienisch und energiesparend belüften und kühlen können. Sie können in ihren Ordinationen durch frühmorgendliche Öffnung und durch Vorbereitung auf Hitzekrankheiten dabei helfen, die Spitäler vor Überlastung zu schützen. Krankheiten durch neue Allergene und
alte Tropenkrankheiten, die nun auch bei uns heimisch werden, wollen erkannt und behandelt werden. Ärzt:innen wollen und sollen wissen, wie sie in Spital und Praxis dazu beitragen können, den großen Fußabdruck des Gesundheitswesens zu verkleinern.“
Aufruf an die Politik
Damit eine nachhaltige Anpassung der Pflichtcurricula gelingen kann, müssen allerdings die Voraussetzungen dafür auf Bundes- bzw. Landesebene geschaffen werden. Das forderte eine breite Vereinigung von Vertreter:innen der Gesundheitsberufe bereits Anfang des Jahres in einem offenen Brief an die Bundesminister:innen für Gesundheit, Klima, Bildung und Finanzen. Neben dem organisierenden Verein Health for Future Austria* unterzeichneten diesen rund 30 Akteure im österreichischen Gesundheitssektor – darunter das Bündnis Nachhaltige Hochschulen, die Universität für Bodenkultur Wien, die Apothekerkammer, der Gesundheits- und Krankenpflegeverband, der Dachverband der geho-
benen medizinisch-technischen Dienste sowie die Österreichische Ärztekammer. „Besonders wichtig in Zeiten der Krise ist es, Hoffnung zu geben und den Gewinn an Vitalität durch Co-Benefits darzustellen – wie klimafreundliche Ernährung, Alltagsbewegung, weniger Hetze und Kaufsucht“, betont Dr. Fuchsig. Dabei spielen Beschäftigte im Gesundheitswesen eine zentrale Rolle. AS
* Weitere Informationen: healthforfuture.at
TERMIN
Fachsymposium „Klimawandel, Gesundheit und Resilienz: aktuelle Trends und künftige Entwicklungen in Lehre, Forschung und Praxis in der DACH-Region“, 21.-22. September 2023, Campus Villach.

Siehe Veranstaltungen unter: wechange.de/group/h4f-austria
Auswirkungen der Klimakrise auf die Gesundheit.
Hausärzt:in extra 45 Juni 2023
© HealthForFuture.de
Arzt Sicht Sache
Seitenblicke auf die Medizin
„GPT: Software zur Schwarmverblödung?“

Bereits im Jänner las ich in der WissensKolumne des ZDF (Gert Scobel) die Überschrift „GPT: Eine Software, die die Welt verändert“. Die große Aufregung ist verständlich. Bietet GPT (Generative Pre-trained Transformer) doch an, dass Journalistinnen und Journalisten nur mehr Stichworte in eine AI-Software eingeben müssen. Innerhalb von Sekunden wird, wie von Geisterhand, ein neuer, sprachlich einwandfreier Artikel geschrieben. Doch ist das wirklich ein Fortschritt? Lauert darin nicht eine bisher unbekannte Gefahr? Im Gegensatz zum Begriff der Schwarmintelligenz könnte man diese Art der KI als Software zur „ Schwarmverblödung“ bezeichnen. Aber warum komme ich zu dieser Meinung?

Das Programm im Test
Ich habe selbst in einer kostenlosen Demoversion einen Text zum Thema Reizdarmsyndrom schreiben lassen. Nachdem ich vor kurzem ein Buch darüber veröffentlicht habe, eignete es sich gut zu einem Test. Das Ergebnis verblüffte: Auf dem letzten Stand des Wissens war alles über das Thema zu lesen. Das Problem war aber, dass das Programm nur gängige Meinungen produzierte. Alles, was nicht medienkonform oder gerade „i n“ war, wurde ausgeblendet. GPT stellt also eine Verstärkersoftware für etabliertes Wissen dar, die das Denken im Widerstand gegen die allgemeine Meinung noch weniger zulassen wird, als es bisher durch Impact Factor, BOTS, Social Media etc. ohnedies schon geschieht.
Wenn ein Journalist im Auftrag einer Zeitung schnell einen Artikel über ein Thema schreiben muss, von dem er
eigentlich überhaupt keine Ahnung hat, dann ist diese Software perfekt. Die Betonung liegt auf „ s chreiben über etwas, von dem man keine Ahnung hat “ . GPT ist dafür geeignet, Menschen mit einem oberflächlichen Wissen gebildet erscheinen zu lassen. Ohne sich dessen bewusst zu sein, wird man jedoch schnell zu einem Verbreiter von ungeprüftem Wissen und Fake News oder einfach zu einem Roboter, der alles nachplappert. Wo bleiben die Journalisten, die noch eine (unorthodoxe) Meinung haben? Die ihre Meinung auch vertreten? Die nicht nur schreiben über das, was gelesen wird, sondern über das, was aus ihrer Sicht gelesen werden sollte? Sie glauben, „objektiv“ zu sein, und sind gleichzeitig selbst Opfer des uniformen „korrekten“ Denkens.
Aus der Geschichte lernen
Wissenschafter, die etwas Neues, außerhalb der Lehrmeinung, entdeckt haben, setzen sich also noch schwerer durch. Was schon einmal gedacht wurde, darf wieder gedacht werden. Was noch nicht gedacht wurde, darf auch jetzt nicht gedacht werden. In der Vergangenheit wurden zahlreiche Wissenschafter wie Galileo Galilei Opfer solch einer Anschauung. In der Wissenschaft spricht man auch vom „ Semmelweis-Effekt“: Für seine Empfehlung, vor der Geburtshilfe die Hände zu waschen, wurde der Arzt jahrelang von seinen Kollegen missachtet und ausgelacht. Durch eine Software, die dazu dient, Meinungen zu konsolidieren, egal ob diese richtig oder falsch sind, besteht die Gefahr der sozialen Ausgrenzung von Andersdenkenden und somit der Randgruppenbildung und Radikalisierung
von Menschen, da sie nicht mehr gehört werden (dürfen), weil sie anders denken ... Wie gefährlich eine solche Entwicklung ist, hat man im Lauf der Geschichte an den Religionskriegen gesehen. Alles wurde verteufelt, was unüblich war oder was man nicht verstanden hat. Heute wird die gleiche soziale Reaktion als Mobbing bezeichnet. Die Aufklärung hat uns davon zu einem gewissen Grad befreit, die moderne GPT-Software birgt aber das Risiko, uns wieder in das psychosoziale Mittelalter zurückzuführen. Was die gleichgeschalteten Medien angerichtet haben, konnten wir auch während der Pandemie erleben. Mit der Folge, dass eine zuvor weitgehend friedliche Gesellschaft gespalten wurde. Die Auswirkungen einer solchen selbstverstärkenden Meinungsmacher-Software wird man erst in Jahrzehnten spüren. Aber es stand schon in der Bibel: „ A n ihren Früchten werdet ihr sie erkennen “ Nur: Wem nützt diese Erkenntnis, wenn eine gespaltene Bevölkerung und Glaubenskriege wieder zum Alltag gehören?
X HAUSÄRZT:IN-Buchtipp
Die Wunder der Bibel medizinisch erklärt

46 Hausärzt:in Kommentar Juni 2023
© privat
Von Maximilian Ledochowski Springer Berlin 2023
© shutterstock.com/wan wei
Univ.-Doz. Dr. Maximilian Ledochowski Internist und Ernährungsmediziner i. R. sowie Buchautor, Innsbruck
<
Erste und einzige orale Therapie bei COVID-19
PAXLOVID ®: Die Behandlung sollte möglichst früh begonnen
Auch wenn in Österreich alle CoronaMaßnahmen mit 30. Juni enden: SARSCoV-2 ist gekommen, um zu bleiben. Vor allem für Risikopatient:innen bleiben Prävention und Therapie einer COVID-19-Erkrankung daher auch in Zukunft wichtige Themen.
Relative Risiko-Reduktion für Hospitalisierung oder Tod jeglicher Ursache um 86 %
Für an COVID-19 erkrankte Erwachsene mit erhöhtem Risiko für einen schweren Verlauf, ohne zusätzlichen Sauerstoffbedarf, ist PAXLOVID® zugelassen. PAXLOVID® enthält die beiden Wirkstoffe Nirmatrelvir und Ritonavir: Nirmatrelvir verhindert die Virusreplikation, während Ritonavir für eine höhere Plasmakonzentration von Nirmatrelvir sorgt. Ergebnisse der
IMPRESSUM
Herausgeber und Medieninhaber:
Studie EPIC-HR zeigten für PAXLOVID® im Vergleich zu Placebo bei Therapiestart innerhalb von 5 Tagen nach Symptombeginn ein um 86 % signifikant reduziertes relatives Risiko für Hospitalisierung oder Tod jeglicher Ursache. Die häufigsten Nebenwirkungen waren Geschmacksstörungen, Diarrhö, Kopfschmerzen, Übelkeit und Erbrechen1.
Einnahme zweimal täglich über 5 Tage Eine Behandlung mit PAXLOVID® sollte so rasch wie möglich, spätestens 5 Tage nach Auftritt von Symptomen begonnen werden. Patient:innen nehmen alle 12 Stunden je 2 Tabletten Nirmatrelvir und 1 Tablette Ritonavir ein. Bei mäßiger Nierenfunktionsstörung: 1 Tablette Nirmatrelvir statt 2. Die Behandlung erfolgt über 5 Tage,
werden
auch falls Betroffene rasch eine Besserung spüren1.
Wechselwirkungen beachten Eine gleichzeitige Anwendung von PAXLOVID® mit Arzneimitteln, die CYP3A induzieren oder inhibieren, kann die Plasmakonzentrationen von Nirmatrelvir und Ritonavir verändern. Vor der Anwendung des Arzneimittels muss daher kontrolliert werden, ob Wechselwirkungen mit Komedikationen bestehen1
Die Fach- und Gebrauchsinformation von PAXLOVID®, sowie ein Wechselwirkungs-Checker sind online verfügbar: covid19oralrx.at
Referenz:
1 PAXLOVID Fachinformation, aktueller Stand.
Quelle: Pfizer Corporation Austria Gesellschaft m.b.H.
RegionalMedien Austria Gesundheit – RMA Gesundheit GmbH, Am Belvedere 10 / Top 5, 1100 Wien, Tel. 01/74321708114, office@gesund.at.
Geschäftsführung: Mag.a Birgit Frassl, Marlis Rumler.
Redaktionsleitung: Mag.a Karin Martin.
Redaktion: Mag.a Karin Martin, Anna Schuster, BSc, Mag.a Ines Pamminger, BA, Margit Koudelka, Marcel Toifl.
Lektorat: Mag.a Katharina Maier.
Produktion & Grafik: Angie Kolby.
Cover-Foto: stock.adobe.com/QuietWord.
Verkaufsleitung: Mag.a Birgit Frassl, birgit.frassl@regionalmedien.at.
Kundenbetreuung: Mag.a Dagmar Halper, dagmar.halper@regionalmedien.at, Claudia Szkutta, claudia.szkutta@regionalmedien.at.
Druckerei: Bösmüller Print Management GesmbH & Co. KG. Verlags- und Herstellungsort: Wien.
Grundlegende Richtung: Unabhängige österreichische Fachzeitschrift für niedergelassene Ärztinnen und Ärzte.
Die HAUSÄRZT:IN – Praxis-Magazin für Primärversorgung –ist ein interdisziplinäres Informations- und Fortbildungsmedium.
Aus Gründen der besseren Lesbarkeit verzichten wir in den Artikeln teilweise auf die gendergerechte bzw. gänzlich orthografisch/grammatikalisch korrekte Schreibweise. Sofern nicht anders vermerkt, gelten alle Bezeichnungen für sämtliche Geschlechter.
Namentlich gekennzeichnete Beiträge geben nicht unbedingt die Meinung der Redaktion oder des Verlages wieder, sondern fallen in den Verantwortungsbereich der Autor:innen. Der Inhalt von entgeltlichen Einschaltungen und Beilagen sowie die Angaben über Dosierungen und Applikationsformen liegen außerhalb der Verantwortung der Redaktion oder des Verlages und sind vom/von der jeweiligen Anwender:in im Einzelfall auf ihre Richtigkeit zu überprüfen. Nachdruck nur mit schriftlicher Genehmigung des Verlages. Alle Rechte, insbesondere das Recht der Vervielfältigung und Verbreitung sowie der Übersetzung, vorbehalten. Kein Teil des Werkes darf in irgendeiner Form (Fotokopie, Mikrofilm oder ein anderes Verfahren) ohne schriftliche Genehmigung des Verlages reproduziert oder unter Verwendung elektronischer Systeme gespeichert, verarbeitet, vervielfältigt, verwertet oder verbreitet werden.
Mit „Bezahlte Anzeige“ gekennzeichnete Beiträge/Seiten sind gemäß §26 Mediengesetz bezahlte Auftragswerke.
Offenlegung: gesund.at/impressum
47 Juni 2023 Hausärzt:in informativ
PP-PAX-AUT-0103/05.2023 Fachkurzinformation siehe Seite 50
Hausärzt:in fachkurzinformation 48 Juni 2023
Mit der Kraft des Arzneilavendels
Angststörungen: Wirksame und sichere Therapie mit Lasea®


Angststörungen zählen noch vor Schlafstörungen und unipolaren Depressionen zu den häufigsten psychischen Erkrankungen. Zur Therapie liegt in Österreich ein Arzneimittel vor, das klinische Wirksamkeit und gute Verträglichkeit optimal kombiniert.
Therapeutische Lücke geschlossen
Zur medikamentösen Behandlung stehen synthetische Arzneimittel wie Benzodiazepine, SSRIs oder SNRIs zur Verfügung. Sie sind hochwirksam, jedoch für eine längere Anwendung ungeeignet. Phytotherapeutika mit Extrakten von Passions-
blume oder Johanniskraut haben im Gegensatz dazu ein gutes Sicherheitsprofil, jedoch keine klassische Indikation für Angststörungen.
Die therapeutische Lücke zwischen synthetischen und pflanzlichen Arzneimitteln schließt Lasea®, ein auf Arznei-Lavendelöl basierendes Präparat mit der Wirkstoffbezeichnung Silexan®, das zur Behandlung temporärer ängstlicher Verstimmung zugelassen ist. Die klinische Wirksamkeit und Sicherheit wurden in rund 15 Studien an mehr als 2.200 Proband:innen bestätigt. Lasea® weist außerdem ein hohes Sicher-
heitsprofil und eine gute Verträglichkeit auf. Patient:innen sind im Alltag durch die Einnahme von Lasea® nicht eingeschränkt und es treten keine Wechselwirkungen mit anderen Medikamenten auf.1
Referenz:
1 Doroshyenko O et al., Drug cocktail interaction study on the effect of the orally administered lavender oil preparation Silexan on cytochrome P450 enzymes in healthy volunteers. Drug Metab Dispos 2013;41:987–993.
Quelle: Schwabe Austria
Depot-Substitution in der gelben Box
Buvidal®: minimiertes Missbrauchsrisiko und höhere Patient:innenzufriedenheit
Buvidal® ist ein subkutan zu injizierendes Buprenorphin-Präparat, das seit 1. Juni 2023 in der gelben Box (RE1, SG-Rezept) verschreibbar ist.1 Buvidal® kann wöchentlich oder monatlich in jeweils vier unterschiedlichen Dosierungen verabreicht werden.2 Es erhöht die Flexibilität der Patientinnen und Patienten und erspart ihnen die tägliche Einnahme eines Substitutionsmittels in der Apotheke. Das Missbrauchsrisiko ist minimiert – das Depot verteilt sich unter der Haut. 2-3 Im Vergleich zu sub-
lingualem Buprenorphin besteht bei der Behandlung mit Buvidal® ein verbessertes Beigebrauchsverhalten. 2,4-5 Die DEBUT-Studie zeigt, dass Buvidal® zu einer höheren Patientenzufriedenheit als sublinguales Buprenorphin führt.6
Zu den subjektiven Gründen für eine Umstellung auf Buvidal® gehören Unzufriedenheit mit der aktuellen Substitution und der Wunsch nach einer besseren Behandlung.7 Eine ausführliche Aufklärung der Patienten hat einen positiven Einfluss auf den Umstellungserfolg.
Adaptives Kompressionssystem mit Selbstversorgungsoption
ReadyWrap® von L&R jetzt erstattungsfähig für Indikation „Venöses Ödem“
Seit Jänner 2023 ist ReadyWrap, das medizinische adaptive Kompressionssystem von Lohmann & Rauscher (L&R), auch in der Phlebologie für die Indikation „Venöses Ödem“ erstattungsfähig. Bereits seit Jänner 2017 ist dies bei der Indikation Lymphödem der Fall. Das Besondere des Produkts: ReadyWrap kann von Patient:innen oder deren Angehörigen selbst angelegt und angepasst werden. Diese Selbstversor-
gungsoption vereinfacht die Kompressionstherapie und bringt mehr Eigenständigkeit für die Patient:innen und eine Entlastung des Pflegepersonals bzw. allgemein des Gesundheitssystems mit sich. Eine randomisiert kontrollierte Studie, die an der Berliner Charité durchgeführt wurde, bestätigt die Wirksamkeit von ReadyWrap – auch wenn Patient:innen das Produkt selbst anlegen.1-2
Literatur:
1 sozialversicherung.at/oeko/views/index.xhtml
2 Fachinformation Buvidal, Camurus AB, Stand Juni 2021.
3 Benyamina A, Stöver H, Heroin Addict Relat Clin Probl. 2012;14(4):65–80.
4 European Medicines Agency: EMA/693347/2018Buvidal ® : EPAR - Public assessment report 2018.
5 Lofwall MR et al., JAMA Intern Med. 2018;178(6); 764–773.
6 Lintzeris N et al., JAMA Netw Open 2021;4(5): e219041.
7 Barnett A et al., Drug and Alcohol Dependence. 2021;108959.
Referenzen:
1 Reißhauer A et al., Phys Med Rehab Kuror 2020; 30(04): 214-221.
2 Reißhauer A et al., Phlebologie 2021; 50(05): 313-319.
Quelle: Lohmann & Rauscher GmbH & CoKG
Hausärzt:in informativ 49 Juni 2023 LAS_PR1500_2305_F
Fachkurzinformation siehe Seite 50
Fachkurzinformation siehe Seite 50
Quelle: Camurus Austria GmbH
© Lohmann & Rauscher GmbH & CoKG
Anlage von ReadyWrap am Unterschenkel.
Hausärzt:in fachkurzinformation 50 Juni 2023
Neuer Dengue-Fieber-Impfstoff wird in Wien geprüft
Takeda feiert Eröffnung des Global Pathogen Safety Labors
Der global bedeutende Impfstoff Qdenga® gegen das in tropischen und subtropischen Regionen weitverbreitete DengueFieber steht nun in Österreich erstmalig als Reiseimpfung zur Verfügung. Der neue Impfstoff ist für alle ab dem Alter von 4 Jahren erhältlich. Er wurde in einem umfangreichen klinischen Entwicklungsprogramm mit mehr als 28.000 Teilnehmer:innen geprüft, einschließlich der Phase-3-Studie TIDES.
Neu ist auch ein Erweiterungsbau in einem Spezial-Labor von Takeda in Wien, das den
Impfstoff auf Sicherheitsaspekte testen wird. Am Wiener Produktionsstandort von Takeda finden alle Prozessschritte für die Herstellung innovativer Arzneimittel statt. Ein wesentlicher Teil der Wertschöpfungskette ist die Sicherstellung der Qualität und Sicherheit aller Produkte. Rund um die Industriestraße im 22. Wiener Gemeindebezirk befinden sich die Gebäude und Betriebsgelände des campusartig aufgebauten Arzneimittel-Produktionsbetriebs von Takeda. In einem dieser Gebäude ist eine ganz besondere Expert:innen-
Neues vom EAS-Kongress
Bempedoinsäure reduziert das
Im Rahmen einer Late-Breaker-Sitzung beim 91. Kongress der European Atherosclerosis Society (EAS) wurden erstmalig die Daten der CLEAR OutcomesStudie* sowie der internationalen Beobachtungsstudie SANTORINI** in Europa vorgestellt.
• Bempedoinsäure ist ein ACL-Hemmer, der als orale lipidsenkende Therapie sowohl effektiv den LDL-CSpiegel als auch signifikant das Risiko für schwerwiegende kardiovaskuläre Ereignisse senkt.1
Organisation tätig: Die Gruppe Global Pathogen Safety. In diesem branchenführenden globalen Kompetenzzentrum wachen anerkannte Virolog:innen mit langjähriger Expertise über die Qualität und Sicherheit aller biologischen TakedaProdukte. In diesem Gebäude wird in Zukunft der neu zugelassene Impfstoff gegen Dengue-Fieber auf Sicherheitsaspekte getestet. So schafft dieser für die globale Anwendung entwickelte Impfstoff auch kontinuierliche Wertschöpfung in Österreich.
Quelle: Takeda Pharma Ges.m.b.H.
Risiko schwerer kardiovaskulärer Ereignisse
• Die Daten der CLEAR OutcomesStudie zu Bempedoinsäure belegen eine Reduktion des relativen Risikos für schwere kardiovaskuläre Ereignisse um 13 %*** bei Patient:innen mit einer arteriosklerotischen Herz-Kreislauf-Erkrankung (ASCVD) oder mit hohem ASCVD-Risiko und erhöhtem LDL-C.1
• Daten der SANTORINI-Studie legen nahe, dass die Anwendung von Kombinationstherapien als Therapiestandard die Zahl der Patient:innen erhöht,
welche die in den Leitlinien empfohlenen LDL-C-Zielwerte erreichen.2
Referenzen:
1 Nissen SE et al., N Engl J Med 2023. 13;388(15): 1353–1364.
2 Ray KK et al., Datenpräsentation beim Kongress der EAS 2023.
* CLEAR: Cholesterol Lowering via Bempedoic acid, an ATP citrate lyase (ACL)-Inhibiting Regimen.
** SANTORINI: Lipidmanagement bei Patient:innen mit hohem oder sehr hohem kardiovaskulärem Risiko; Daten aus der klinischen Praxis in Europa.
*** Die Prozentsätze aus öffentlich zugänglichen Quellen wurden auf die nächste ganze Zahl gerundet.
Quelle: Presseaussendung Daiichi Sankyo (24.5.2023)
51 Juni 2023 Fachkurzinformation siehe Seite 50 Hausärzt:in informativ
Fachkurzinformation siehe Seite 50 Fachkurzinformation siehe Seite 50,51
Femalen
® für Frauen in den Wechseljahren
und forte
Verbesserung der Wechseljahresbeschwerden anhand Fragebogen und visuellen Analogskalen*
nächtliches Schwitzen -62% -55% -56%
Hitzewallungen -68%
Reizzustände -60%
Schlafprobleme
Müdigkeit
Æ 96 % der Anwenderinnen sind zufrieden
Tägliche Verzehrsmenge und Anwendung
Femalen® forte: 1 Kapsel täglich

Femalen®: 2 Tabletten täglich

Wichtig: Empfehlen Sie, in den ersten 2 Monaten Femalen® oder Femalen® forte ohne Unterbrechung einzunehmen, damit die Eigenschaften der enthaltenen Stoffe voll zur Entfaltung kommen können. Eine Daueranwendung ist bedenkenlos möglich.
* Druckmann, Lachowsky, Elia; Genesis 2015; 183:10-13
Offene klinische Multicenter-Studie, 324 Frauen - 90 Gynäkologen, 2 Tabletten tgl., 3 Monate Nahrungsergänzungsmittel für Frauen in den Wechseljahren mit Pflanzenpollenextrakt und Vitamin E. Nahrungsergänzungsmittel sollten nicht als Ersatz für eine ausgewogene und abwechslungsreiche Ernährung sowie eine gesunde Lebensweise dienen. AT/Femalen/2023002

Zusammensetzung Femalen® forte 1 Kapsel Femalen® 2 Tabletten Pflanzenpollenextrakt 320 mg 320 mg Vitamin E 10 mg 10 mg
Tägliche Verzehrsmenge

Anna Schuster, BSc
Anna Schuster, BSc








































































